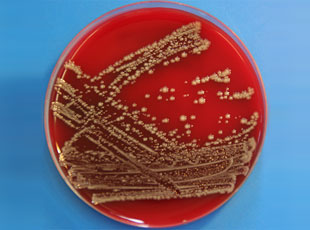

| Zentraler Post- & Probeneingang: 42555 Velbert Wilhelm-Teleu-Weg 34 Fon: 02052-800591 Fax: 02052-800592 |
Sekretariat: 40597 Düsseldorf Am Mönchgraben 56 Fon: 0211-41604-30 Fax: 0211-41604-36 |
Niederlassung: 87561 Oberstdorf Aurikelstraße 3 Fon: 08322-2188 Fax: 08322-2188 |

| Zentraler Post- & Probeneingang: 42555 Velbert Wilhelm-Teleu-Weg 34 Fon: 02052-800591 Fax: 02052-800592 |
Sekretariat: 40597 Düsseldorf Am Mönchgraben 56 Fon: 0211-41604-30 Fax: 0211-41604-36 |
Niederlassung: 87561 Oberstdorf Aurikelstraße 3 Fon: 08322-2188 Fax: 08322-2188 |
|
Beeinträchtigungen durch biologische Ursachen
Wohngebäude und Innenräume können von unterschiedlichen biologischen Organismen befallen werden, die die Gesundheit der Bewohner, den Wohnwert oder auch die statische Standsicherheit beeinträchtigen können. Am häufigsten ist Schimmelpilzbefall anzutreffen. Schimmelpilze sind Teil unserer natürlichen Umwelt. Im Laufe der Evolution haben sich die Pilze über Millionen von Jahren ideal darauf angepasst, auf vorhandener Biomasse zu wachsen. Dabei sind sie sehr anspruchslos, es können praktisch alle Arten organischen Gewebes (z.B. Holz, Papier, aber auch Weichmacher aus Kunststoffen) als Substrat dienen. Die Biomasse wird dabei zersetzt und zu anorganischen Substanzen abgebaut, die als wichtige Nährstoffgrundlage für andere Lebewesen wie z.B. Pflanzen dienen. Schimmelpilze sind also ideale "Recycler". In Innenräumen sind Schimmelpilze dagegen zu Recht höchst unerwünscht. Seltener wird ein Befall mit Bakterien diagnostiziert. Meist wird dies durch den Austritt von mit Fäkalien belastetem Abwasser verursacht. Bakterien können sich unter normalen Umständen in Gebäuden nicht vermehren, bilden jedoch bei Trockenheit Dauerformen aus, die leicht luftgetragen sind und Menschen in der Umgebung infizieren können. Klima- und Lüftungsanlagen können bei unsachgemäßer Konstruktion bzw. unzureichender Wartung eine Vielzahl von Pilzen und Bakterien beherbergen. Zusätzlich können vorgeschaltete Erdwärmetauscher eine massive bakteriologische und Schimmelpilzbelastung aufweisen. Vor allem in älteren Gebäuden mit tragender Holzstruktur findet sich nach längerem Einwirken von Feuchtigkeit Befall mit Holz zerstörenden Pilzen (z.B. echter Hausschwamm). Während Schimmelpilze nur oberflächlich auf Holz wachsen, bauen Holz zerstörende Pilze die Holzsubstanz bis in die Tiefe ab und können innerhalb kurzer Zeit die statische Standsicherheit eines Gebäudes massiv beeinträchtigen. Vorgehensweise bei bestehendem oder vermutetem Befall mit biologischen Ursachen 1. Kontaktaufnahme und Besprechung der Vorgehensweise mit allen Beteiligten 2. Begehung des Gebäudes/der Wohnung durch unseren Sachverständigen für Innenraumanalytik. Dokumentation der Ergebnisse 3. wenn notwendig: Probennahme (Luft- und/oder Materialproben) mit anschließender Gattungs- und Artbestimmung im eigenen mikrobiologischen Labor. Schneller Vorbefund von Material- und Staubproben innerhalb 24 Stunden. Charakterisierung und Quantifizierung der Pilze oder Bakterien innerhalb weniger Tage* 4. Das Abschlussgutachten beantwortet die Fragen zur gesundheitlichen Relevanz, Ursache, Sanierungsdringlichkeit und langfristigen Abhilfemaßnahmen 5. telefonische Beratung bei Unklarheiten und offenen Fragen *Bei Kontakt- und Luftproben bestimmen die unterschiedlichen Wachstumsgeschwindigkeiten die Schnelligkeit der Analyse. Dieses Vorgehen garantiert eine schnelle Problemerkennung und hilft, wertvolle Zeit bei der Beseitigung der Ursachen zu sparen. Wir richten uns dabei u.a. streng nach den Vorgaben des A) Umweltbundesamtes, niedergelegt im "Leitfaden zur Vorbeugung, Untersuchung, Bewertung und Sanierung von Schimmelpilzwachstum in Innenräumen" von 2002, erstellt durch die Innenraumlufthygienekommission des Umweltbundesamtes, B) Landesgesundheitsamtes Baden-Württemberg, niedergelegt im Leitfaden "Schimmelpilze in Innenräumen - Nachweis, Bewertung, Qualitätsmanagement" von Dezember 2004. Bei Interessenskonflikten zwischen Mietern und Vermietern ist eine gemeinsame Beauftragung von DomoLytik, Institut für Gebäude- und Innenraumanalytik sinnvoll, um entstehende Kosten zu minimieren und eine schnelle Lösung zu finden. Gerne werden wir aber auch für eine der beiden Parteien tätig.  DomoLytik Institut für Gebäude- und Innenraumanalytik GmbH
Kontakt aufnehmen
Schimmelpilze in Gebäuden
Schimmelpilze sind Teil unserer natürlichen Umwelt. Im Laufe der Evolution haben sich die Pilze über Millionen von Jahren ideal darauf angepasst, auf vorhandener Biomasse zu wachsen. Dabei sind sie sehr anspruchslos, es können praktisch alle Arten organischen Gewebes (z.B. Holz, Papier, aber auch Weichmacher aus Kunststoffen) als Substrat dienen. Die Biomasse wird dabei zersetzt und zu anorganischen Substanzen abgebaut, die als wichtige Nährstoffgrundlage für andere Lebewesen wie z.B. Pflanzen dienen. Schimmelpilze sind also ideale "Recycler". In Innenräumen sind Schimmelpilze dagegen zu Recht höchst unerwünscht. Schimmelpilze setzen zu ihrer Vermehrung Millionen von winzigen Sporen frei, die die Luft kontaminieren, die wir einatmen.  Dadurch können eine Vielzahl von Krankheiten ausgelöst und gefördert werden, die jedoch auf Grund der Variabilität der Ausprägung und der Symptome oft nur schwierig diagnostiziert werden können: - Allergien (Schimmelpilze sind das dritthäufigste Allergen nach Pollen und Milben.) - Atemwegserkrankungen (Husten, Schnupfen, Entzündungen der Nebenhöhlen) - Augenentzündungen und Schleimhautreizungen - Kopfschmerzen - Vergiftungen (durch Mykotoxinen, z.B. Stachbotrys chartarum, Aspergillus flavus) - Infektionen (sehr selten bei gesunden Menschen) Häufig können die Ursachen dieser Erkrankungen mangels fehlender Innenraumanalytik nicht erkannt und somit nur Symptome und nicht Ursachen bekämpft werden. Erfahrungsgemäß stellen Schimmelpilze ein besonderes Gefährdungspotenzial dar für: - Personen mit eingeschränkter Lungenfunktion - immunsupprimierte Personen - immungeschwächte Personen - Säuglinge und Kleinkinder - Allergiker.  DomoLytik Institut für Gebäude- und Innenraumanalytik GmbH
Kontakt aufnehmen
Biologie der Schimmelpilze
Schimmel ist ein umgangssprachlicher Sammelbegriff für eine heterogene Gruppe von Pilzen. Der Biologe versteht darunter Fadenpilze aus mehreren Pilzgruppen (Zygomyceten, Ascomyceten, Fungi imperpecti). Die einzelnen Schimmelpilzarten werden mit einem lateinischen Doppelnamen bezeichnet, wobei der erste Namensteil die Gattung (z.B. Stachybotrys, Penicillium, Aspergillus etc.) und der zweite Namensteil die Art (Stachyobotrys chartarum, Penicilium chrysogenum, Aspergillus flavus etc.) charakterisiert. Schimmelpilze werden oft als faseriger, flockiger und vielfältig gefärbter Überzug auf organischem Material sichtbar.  Verbreitung Zuerst bildet sich aus einer zufällig auf die Unterlage gefallenen Schimmelpilzspore eine fädige Struktur, das sogenannte Myzel. Dieses besteht aus mikroskopisch kleinen Pilzfäden, die sich nach allen Seiten ausbreiten. An ihrer Spitze wachsen sie mit großer Geschwindigkeit weiter, so dass der Schimmel schnell große Flächen überwuchern kann. Als heterotrophe Organismen ernähren sich Schimmelpilze von organischem Material. In Gebäuden zählen dazu: Tapete, Kleister, Karton, Holz, Weichmacher in Kunststoffen etc.. Gefährdungspotenzial Schimmelpilze stellen ein eindeutiges, leider vielfach immer noch unterschätztes Gesundheitsrisiko dar. Neben dem direkten Wachstum auf menschlichen Organen (Mykosen, ausgelöst z.B. durch Aspergillus fumigatus), das vor allem bei immungeschwächten und immunsupprimierten Personen eine Rolle spielt, weisen viele Schimmelsporen ein hohes allergisches Potenzial auf. Auch können Stoffwechselprodukte (Mykotoxine, z.B. von Stachybotrs chartarum oder Aspergillus flavus) stark toxisch und kancerogen (d.h. krebserregend) sein. Zur Minimierung des Gesundheitsrisikos sind daher von der EU und dem Umweltbundesamt Richtwerte für die Schimmelpilzbelastung festgelegt, die nicht überschritten werden sollten. Andernfalls besteht dringender oder sehr dringender Handlungsbedarf. In Extremfällen (abhängig von Art und/oder Menge des Befalls) kann eine sofortige Schließung der Räume oder der Auszug aus der Wohnung notwendig sein. Wachstumsbedingungen: Die Voraussetzungen Schimmelpilzwachstum in Innenräumen setzt drei Bedingungen voraus: - Nährstoffangebot - Temperatur - Feuchtigkeit Zwei Voraussetzungen sind in Gebäuden immer vorhanden: - ausreichendes Nährstoffangebot aus Zellulose (Tapeten, Kleister, Holz und Holzwerkstoffe, Gipskartonplatten, Baumwoll- oder Leinengewebe, Staub) oder anderem organischen Material - ideale Wachstumstemperaturen zwischen 15�C und 25�C für die meisten Schimmelpilzarten. Kommt jetzt auch noch Feuchtigkeit z.B. nutzungsbedingt durch kondensierende Raumluftfeuchtigkeit oder gebäudebedingt durch direkten Wassereintrag (etwa nach Rohrbrüchen, Dach- und Fassadenundichtigkeiten oder eindringendes Wasser im Kellerbereich) hinzu, sind alle Startbedingungen für das Schimmelpilzwachstum gegeben. Sind keine gebäudebedingten Schwachstellen vorhanden, lässt sich in Innenräumen die Raumluftfeuchtigkeit nutzungsbedingt steuern. Beispielsweise setzt ein Dreipersonenhaushalt durch Waschen, Baden, Kochen, Geschirrspüler und Wäschetrocknung täglich bis zu 14 Liter Wasser in Form von Luftfeuchtigkeit in die Wohnung frei. Die Feuchtigkeit schlägt sich an den kältesten Stellen in der Wohnung nieder, wo nicht nur Fenster beschlagen, sondern sich auch Feuchtigkeitsschäden an schlecht isolierten Wänden bilden können. Auch oberhalb des Taupunktes, also ohne die sichtbare Kondensation von Luftfeuchtigkeit, kann es zu Schimmelpilzbefall kommen. Die Ursachen Man unterscheidet grundsätzlich zwischen nutzungsbedingten und gebäudebedingten Ursachen für den Schimmelpilzbefall von Gebäuden. Nutzungsbedingter Befall von Schimmelpilz durch - kein oder fehlerhaftes Lüftungsverhalten - ungenügendes Heizen der Wohnung oder einzelner Räume - mangelnde Luftzirkulation hinter Möbeln und Gardinen an Außenwänden. Baulichbedingter Befall von Schimmelpilz durch - defekte Dächer und Dachrinnen - defekte Rohrleitungen (Wasserrohre, Heizungsrohre, Abwasserleitungen) - Risse in Außenbauteilen (Fensterfugen, Bauteilfugen, Rohr- und Kabeldurchführungen) - schlechte Belüftungssysteme - Baufehler - Kältebrücken - unzureichende Wärmedämmung. Die richtige Erkennung der Ursachen ist Voraussetzung für die erfolgreiche und nachhaltige Beseitigung der Schimmelpilzproblematik. Gesundheitsrisiken Oft wird Schimmelpilzbefall erst entdeckt, wenn dunkle Flecken an der Wand sichtbar werden oder ein moderig, muffiger Geruch wahrzunehmen ist. Diesen bemerken die Bewohner selbst oft gar nicht (oder nur, wenn sie nach längerer Abwesenheit zurückkommen). Lediglich Besuchern fällt er auf. Der typische Schimmelgeruch wird von MVOC (Microbial Volatile Organic Compounds) verursacht. Neben der Geruchsbelästigung bzw. optischen Beeinträchtigung kann Schimmelpilzbefall nicht nur Beschwerden wie Kopfschmerzen und Unwohlsein auslösen, sondern auch schwere Erkrankungen verursachen. Zahlreiche epidemiologische Studien belegen einen Zusammenhang zwischen Schimmelpilzen in Innenräumen und Atemwegserkrankungen oder Allergien. Sie erkennen ein 1,5- bis 3,5-fach erhöhtes Risiko bei Kindern für eine Erkrankung der Atemwege, die in schimmelpilzbelasteten Wohnungen leben. Bei Säuglingen wurde in einer aktuellen Studie sogar ein 7-fach erhöhtes Risiko für Atemwegsinfektionen aufgezeigt. Schimmelpilze können dabei auf drei Arten und Weisen zu Gesundheitsbeeinträchtigungen führen: 1) Der Schimmelpilz bildet Giftstoffe (Mykotoxine), die er an die Umwelt abgibt. Sie wirken auf den Menschen gesundheitsschädigend, wenn schimmelpilzbelastete Lebensmittel über die Nahrung oder eben kontaminierte Raumluft über die Lunge in den Organismus gelangen. 2) Der Schimmelpilz infiziert Körpergewebe (Aspergillosen, Mykosen, z.B. im Lungengewebe). Auskeimende Sporen, die über die Raumluft aufgenommen wurden, nutzen dazu das Gewebe als Nahrungsgrundlage. Bei gesunden (immunkompetenten) Menschen ist dies in der Literatur in Einzelfällen für Aspergillus fumigatus beschrieben, bei immungeschwächten Patienten (nach Organtransplantation, bei HIV-Erkrankung, bei onkologischer Therapie etc.) können auch andere Schimmelpilzarten (Aspergillus flavus, Aspergillus niger u.a.) infektiös sein. Mit fortschreitendem Verlauf (invasive Aspergillose) werden die Heilungschancen geringer. 3) Längerer und/oder wiederholter Kontakt mit Schimmelpilzen, Schimmelpilzsporen, und selbst abgestorbenen Schimmelpilzbestandteilen kann zu allergischen Reaktionen führen. Zudem führen medizinische Studien eine Vielzahl von unspezifischen Symptomen wie Kopfschmerzen, Hustenreiz, Müdigkeit und Schleimhautreizungen an. Aufgrund mangelnder medizinisch-belegter Ergebnisse auf diesem Gebiet kann nicht mit Sicherheit gesagt werden, ab welcher Sporenmenge eine Infektion zu erwarten ist (bzw. unterhalb welcher Menge eine Erkrankung auszuschließen ist). Richtwerte für Schimmelpilzbelastung Gesetzlich vorgeschriebene Grenzwerte der Schimmelpilzbelastung sind zurzeit weder in Deutschland geschweige denn europaweit vorhanden. Da die Schimmelpilzbelastung jahreszeitbedingt auftritt und zudem starken geographischen Schwankungen unterliegt, fällt eine sinnvolle Festlegung von Grenzwerten schwer. Es gibt jedoch Richtlinien der EU und des Umweltbundesamtes, die Sanierungsbedarf anzeigen, wenn die Schimmelpilzkonzentration in Innenräumen deutlich erhöht gegenüber der Außenluft ist. Bei der Messung von Schimmelpilzsporen ist eine Innenraumquelle nicht auszuschließen, wenn die Anzahl der Kolonie-bildenden-Einheiten (KBE) das 1,5-Fache der Außenluft übersteigt, und wahrscheinlich, wenn dieser Wert über dem 2-Fachen liegt. Noch wichtiger ist die festgestellte Schimmelpilzart. Während einige Arten auch in Blumenerde und Biomüll in stark erhöhter Konzentration auftreten können, sind andere Arten viel enger mit Bauschäden verknüpft. Generell soll ein Schimmelpilz, der eine eindeutige Gesundheitsbeeinträchtigung hervorruft, kritischer bewertet werden und schneller zu Sanierungsmaßnahmen führen. Bei Analysen und der Bewertung der Schimmelpilzbelastung richten wir uns nach den Richtlinien des Umweltbundesamtes und den Handlungsempfehlungen des Landesgesundheitsamtes Baden-Württemberg.  DomoLytik Institut für Gebäude- und Innenraumanalytik GmbH
Kontakt aufnehmen
Erkennung der Schimmelpilzbelastung
Der Weg ins Gebäude Schimmelsporen sind überall in der Luft vorhanden und kommen durch Türöffnungen und Fenster ins Haus. Auch Klima- und Lüftungsanlagen können Schimmelsporen in großer Menge im Gebäude verteilen. Stimmen Feuchtigkeit, Temperatur und Nährstoffangebot, treffen die Sporen optimale Wachstums- und Vermehrungsbedingungen an. Sichtbarer Schimmel - auf z.B. Tapeten oftmals schwarz - moschusartig, erdiger Geruch Ist visuell schon Schimmelpilzbefall festzustellen, werden Materialproben entnommen. Die Proben werden anschließend im Labor charakterisiert und die mögliche Gesundheitsgefährdung bestimmt. Versteckter Schimmel - hinter Abmauerungen, unter Teppichböden, in Lüftungsschächten - moderiger und muffiger Geruch (durch Stoffwechselprodukte (MVOC) des Pilzes) Ist der Schimmelbefall nicht direkt sichtbar, werden Raumluftproben genommen. Die Untersuchung von Luftproben ist auch zusätzlich zur Analyse der Materialproben sinnvoll, da dadurch die direkte, vom Menschen eingeatmete Sporen/Partikelbelastung bestimmt wird. Zusätzlich können Staubproben Aufschluss über versteckte Kontaminationen geben Art und Menge der Verschmutzung Typisierung Zur Erfassung der unterschiedlichen Schimmelpilzarten werden verschiedene, auf die diversen Schimmelpilzklassen adaptierte, Nährmedien eingesetzt. Durch selektives Wachstum und unterschiedliche mikroskopische Formen ist die Artbestimmung des Pilzes sicher möglich. Ist die Art des Pilzes charakterisiert, wird geklärt, ob und welche toxische oder krankheitserregende Bedeutung diesem Pilz zukommt. Konzentrationsbestimmung Neben der Artbestimmung werden die gewachsenen Kolonien quantitativ bewertet. Die Daten werden bei gesammelten Luftproben auf die Kolonie-bildenden-Einheiten (KBE) pro m³ Raumluft hochgerechnet. Materialproben, Kontaktproben oder Abklatschproben Ist ein Schimmelpilzbefall sichtbar, wird die direkte Entnahme von belasteten Materialproben (Tapete, Holz etc.) für die Beurteilung einer Kontamination herangezogen. Nach Zerkleinerung des Materials im Labor werden die Proben aufgearbeitet, auf unterschiedlichen Nährböden bei verschiedenen Inkubationsbedingungen kultiviert und so die Schimmelpilze der Gattung bzw. Art nach charakterisiert.  Zur Beurteilung der möglichen Belastung wird die befallene Fläche und Tiefe berücksichtigt. Ist der Schimmel eindeutig eingestuft, wird die gesundheitliche Relevanz beurteilt (Dringlichkeit zur Sanierung, notwendige Schutzmaßnahmen). Die Analyse von Materialproben beantwortet ebenfalls die Frage, ob es sich um einen aktiven Befall oder einen ausgetrockneten Altschaden handelt, der möglicherweise noch Spätfolge eines behobenen Bauschadens (Rohrbruch etc.) ist. Lassen sich keine direkten Materialproben entnehmen, wird zu einer ersten Einschätzung der Belastung eine Abklatschprobe der Oberfläche direkt auf eine Nährmediumplatte gegeben. Durch eine zusätzliche Kontaktprobe auf Adhäsivfilm (an dem alle Oberflächenbestandteile anhaften) wird schnell klar, welcher Art die vorliegende Belastung ist (z.B. Ruß, Salzausblühungen, Fogging, Bläuepilze, Holz zerstörende Pilze). Raumluftmessungen Messung von Schimmelpilzsporen Raumluftmessungen erfolgen mit einem Luftkeimsammler. Mit diesem geeichten Gerät wird eine definierte Luftmenge angesaugt und die darin enthaltenen Sporen auf eine Nährmediumplatte abgeschieden. Nach dem Inkubieren der Platten im Labor werden die gewachsenen Kolonien gezählt. Die sogenannten Kolonie-bildenden-Einheiten (KBE) werden anhand der bekannten, gesammelten Luftmenge auf standardisierte Einheit KBE/m³ hochgerechnet. Durch selektives Wachstum und unterschiedliche mikroskopische Formen ist die sichere Artbestimmung des Pilzes möglich. Bei allen Messungen wird zusätzlich eine Außenluftprobe analysiert, um die Menge und die Artenverteilung des "natürlichen" Hintergrundes zu bestimmen.
Messung von Partikeln Zusätzlich zur Messung der lebenden, keimfähigen Sporen wird die Menge der abgestorbenen Sporen bzw. freigesetzten Zellwandbestandteile gemessen. Diese haben nach wie vor ein möglicherweise hohes mykotoxisches Potenzial sowie ein unverändertes allergologisches Potenzial. Hierbei wird ein definiertes Luftvolumen an einem Objektträger mit Spezialbeschichtung abgeschieden. Durch Partikelmessung werden, z.B. nach oberflächlicher Sanierung und Einsatz von kommerziell erhältlichen Schimmelpilzbekämpfungsmitteln, die noch vorhandene Schimmelpilzbelastung quantifiziert. Messung von MVOC Schimmelpilze geben nicht nur Sporen, sondern auch gasförmige Bestandteile in die Raumluft ab. Diese modrig, faulig riechenden Gase werden als MVOC (Microbial Volatile Organic Compounds) bezeichnet. MVOC-Messungen können bei verdeckten Schimmelpilzbelastungen, bei denen die vergleichbar großen Sporen bzw. Zellwandfragmente nicht freigesetzt werden, eindeutige Hinweise auf eine vorhandene Belastung geben. Sedimentationsproben Hierbei werden Platten mit Nährmedien vom Kunden selber für eine bestimmte Zeit in Innenräumen aufgestellt. Durch passive Sedimentation sollen sich in der Luft vorhandene Sporen auf den in verschiedenen Räumen aufgestellten Platten absetzen. Passive Sedimentation ist jedoch stark größenabhängig, so dass die sehr kleinen Sporen vieler Schimmelpilze unzureichend oder gar nicht erfasst werden. Viele Aspergillusarten sind mit diesem Verfahren nicht nachweisbar. Zudem lassen sich einige der häufigsten und potenziell gesundheitsgefährlichsten Schimmelpilzarten (z.B. Stachybotrys chartarum) nur schwer in der Luft nachweisen. Durch mangelnde Temperaturkontrolle und unterschiedliche Postlaufzeiten etc. wird jegliche Reproduzierbarkeit unmöglich gemacht. Das Umweltbundesamt und das Landesgesundheitsamt Baden-Württemberg kommen zu dem Schluss: "Mit dem Sedimentationsverfahren können daher keine reproduzierbaren und quantitativen Ergebnisse erhalten werden. Es kann daher nicht zum Nachweis kultivierbarer Schimmelpilzsporen bei Luftuntersuchungen im Innenraum empfohlen werden." Staubproben Staubproben können zeitnah erste Hinweise auf eine mögliche Schimmelpilzbelastung geben. Das stark gehäufte Auftreten von einzelnen Arten kann auf die Quelle bzw. die Ursache hinweisen. Eine definierte Menge der Staubprobe wird gesammelt, aufgearbeitet und auf Nährböden kultiviert. Die Anzahl der Kolonie-bildenden-Einheiten (KBE) wird ermittelt; Menge und Art der KBE - verglichen mit Proben aus unbelasteten Gebäuden - indizieren eine Belastungssituation.  DomoLytik Institut für Gebäude- und Innenraumanalytik GmbH
Kontakt aufnehmen
Sanierung der Schimmelpilzbelastung
Abhängig von der Menge, der Ausdehnung und der Art des Pilzbefalls sind schnelle, unterschiedlich umfangreiche Maßnahmen durchzuführen. Die oberflächliche Entfernung des sichtbaren Schimmelpilzes führt häufig nur zu kurzfristigem Erfolg und rein optischer Verschönerung. Neuer Bewuchs wird nicht lange auf sich warten lassen. Zur nachhaltigen Abhilfe bei Schimmelbefall muss die Ursache gefunden werden, um die Lebensbedingungen für Schimmelpilze zu eliminieren.  Hier helfen evtl. schon kurzfristige und schnell durchzuführende - Sofortmaßnahmen wie z.B. eine Umstellung der Möblierung und ein optimiertes Lüftungsverhalten - längerfristige Maßnahmen sind, je nach Art des Befalls, möglicherweise nur bauliche Änderungen. Voraussetzung für eine Sanierungsempfehlung ist immer die richtige und neutrale Ursachenfeststellung bei einer eingehenden Ortsbesichtigung. A) Ursachensuche Voraussetzung für das Wachstum von Schimmelpilzen im Innenraum ist eine erhöhte Feuchtigkeit, die durch Bauschäden, falsches Nutzerverhalten oder beide Faktoren in unterschiedlicher Gewichtung verursacht worden sein kann. Die für das Wachstum notwendige Feuchtigkeit lässt sich konstruktiv und durch das Nutzerverhalten steuern. Beispielsweise setzt ein Dreipersonenhaushalt durch Waschen, Baden, Kochen, Geschirrspülen, Wäschetrocknen, Atmen etc. täglich bis zu 14 Liter Wasser frei, die durch Lüften aus der Wohnung entfernt werden müssen. Deshalb spielt die Beseitigung von Feuchtigkeit die zentrale Rolle bei der Schimmelpilzbeseitigung. Ursachen für Feuchtigkeit durch defekte technische Ausrüstungen und baukonstruktive Fehler können sein: - akute Ereignisse wie Rohrbrüche und Überschwemmungen - Feuchtigkeitsschäden durch eindringendes Regenwasser (Dach, Fassade, Fensterbank etc.) - Feuchtigkeitsschäden durch fehlerhafte Bauwerksabdichtung (Horizontalsperre, Vertikalsperre) - ungenügende Austrocknung im Neubau oder nach Sanierung - Oberflächentauwasser durch Wärmebrücken, teilweise auch in Kombination mit fehlerhaftem Lüften, ungenügendem Heizen und/oder zu geringem Wandabstand Besonders gefährdet sind Küchen, Badezimmer und Schlafzimmer. In diesen Räumen entsteht nutzungsbedingt eine höhere Raumluftfeuchtigkeit. Wenn diese Räume zusätzlich unzureichend beheizt und gelüftet werden, sind Feuchtigkeits- und Schimmelpilzschäden vorprogrammiert. Gefährdete Bauteile sind Außenbauteile (Wände, Decken und Böden) oder Bauteile, die an unbeheizte Räume angrenzen. Außerdem gibt es typische Schwachstellen in der Konstruktion (Kälte- bzw. Wärmebrücken), an denen eine unzureichende Dämmung vorhanden ist (z.B. Fensterstürze, Balkonplatten etc.). Problematisch sind auch Möbelstücke und Gardinen vor Außenwänden. Durch diese Einrichtungsgegenstände entsteht bauphysikalisch eine Art Innendämmung, die zu einer geringeren Oberflächentemperatur der Außenbauteile als Folge der behinderten Luftzirkulation und damit zu einer höheren Feuchtigkeit führt. Eine weitere Gefährdung sind nicht luftdichte Außenbauteile. Durch Undichtigkeiten (Fensterfugen, Bauteilfugen, Rohr- und Kabeldurchführungen) gelangt warme feuchte Luft nach Außen. Auf dem Weg durch die Leckagestelle kühlt sich die warme Luft ab. Dabei nimmt die relative Feuchtigkeit dieser Luft zu und es kann zu Feuchtigkeitsschäden innerhalb des Bauteils kommen. Schimmelpilzbefall ist abzusehen. B) Sofortmaßnahmen Schimmelpilzbildung in Wohngebäuden kann nachhaltig nur durch Begrenzung der Feuchtigkeit verhindert werden. Das mechanische Entfernen des Befalls und die sinnvollerweise vorausgehende Desinfektion bekämpft nur die Symptome, nicht aber die Ursachen. Es gilt grundsätzlich: - ausreichende Be- und Entlüftung der Innenräume sicherstellen - Luftzirkulation (hinter Möbeln, Gardinen) ermöglichen - ausreichend beheizen (auch Schlafzimmer, Küche, Bad) Reinigungstipps bei kleineren Befallsstellen (Ausmaß geringer als ein DIN A5-Blatt) Es sollten nur sehr kleine Bereiche (z.B. oberflächlicher Befall, kleine verschimmelte Stellen an Tapete etc.) selbst gereinigt werden. Dies vermeidet die Verschleppung von Sporen in andere Räumlichkeiten und reduziert die eingeatmete Menge an gesundheitsschädlichen Substanzen. - sichtbarer Befall mit 80% Alkohol (Ethanol, Ethylalkohol, Spiritus) inaktivieren, dies beugt der Verschleppung in angrenzende Gebäudeteile vor. Dabei unbedingt ausreichend lüften und nur Mengen von maximal 100 ml verwenden, um Brand- und Explosionsgefahr zu vermeiden. - betroffene Materialien großzügig entfernen - Untergrund erneut mit 80% Alkohol reinigen (siehe oben) - nie Essig verwenden (an kalkhaltigen Baustoffen wird er neutralisiert und dient dem Pilz als Nährstoff) - Hände, Augen und Lunge schützen (Gummihandschuhe, Schutzbrille und Staubmaske) - Schimmelentferner auf Chlorbasis aus Gesundheitsgründen möglichst nicht verwenden und nie mit anderen Reinigungsmitteln mischen (Entwicklung giftiger Dämpfe) Gehen Sie im eigenen Interesse bei größeren Kontaminationen unbedingt nur mit fachmännischer Hilfe vor. Unsachgemäße Entfernung von belastetem Material kann aus einem kleinen Schaden einen großen Sanierungsfall machen. C) Langfristige Maßnahmen Zur Ursachenbeseitigung bei Schimmelpilzbefall sind oft auch bauliche Maßnahmen notwendig, die für den Nicht-Fachmann nicht unbedingt naheliegend sind: - neue Außendämmung - Sanierung von undichten Installationen und Entwässerungen - Sanierung fehlender/mangelhafter Bauwerksabdichtung - Verbesserung der Bausubstanz auf den Mindestwärmeschutz nach DIN 4108-2 - Verbesserung der Luftdichtheit der Gebäudehülle Je nach Art und Ausmaß der Belastung sollte sehr schnell reagiert werden. Je nach Schimmelpilzart und Menge der Belastung kann ein vorübergehender Auszug aus dem Gebäude erforderlich werden. Während der Sanierung sind ausreichende Maßnahmen zu treffen, um eine Verschleppung der Schimmelpilze in andere Gebäudeteile zu verhindern. Sowohl die Sanierer als auch die Bewohner müssen ausreichend vor Schimmelpilzexpositionen geschützt werden.  DomoLytik Institut für Gebäude- und Innenraumanalytik GmbH
Kontakt aufnehmen
Bakterielle Kontaminationen
Kontaminationen durch Bakterien in Gebäuden können bei Feuchtigkeitsschäden kombiniert mit Schimmelpilzen auftreten. Dabei werden hauptsächlich Actinomyceten gemessen, deren gesundheitliche Relevanz für den Menschen noch nicht geklärt ist. Häufiger treten jedoch Kontaminationen durch Fäkalkeime (z.B. Enterobakterien) nach Undichtigkeiten im Abwassersystem oder Überflutungen mit fäkalienhaltigem Hochwasser auf, wodurch deutliche Risiken für die Gesundheit der Bewohner bestehen. DomoLytik Institut für Gebäude- und Innenraumanalytik GmbH
Kontakt aufnehmen
Bakterielle Kontaminationen als Folge von Feuchtigkeitsschäden
Ein Feuchtigkeitsschaden führt selten allein zu einem Schimmelpilzschaden. Meist finden sich Vergesellschaftungen mit Bakterien z.B. aus der Ordnung der Actinomyceten. Diese können in der Regel lichtmikroskopisch nicht weiter klassifiziert werden, einige Gattungen wie z.B. Nocardia werden jedoch nach der Biostoffverordnung auf Grund einer möglichen Gesundheitsgefährdung der Schutzstufe II zugeordnet. Auch aus diesem Grund sollte jedem Versuch des mechanischen Entfernens von Befallsstellen und belastetem Materials eine gründliche Desinfektion vorausgehen.  DomoLytik Institut für Gebäude- und Innenraumanalytik GmbH
Kontakt aufnehmen
Bakterielle Kontaminationen durch fäkalhaltiges Abwasser
Wurde ein Wasserschaden durch eine Leckage der Abwasserleitung oder fäkalienverschmutztes Abwasser verursacht ist, liegt eine besondere Gefährdungslage vor. Neben einem sich möglicherweise später entwickelnden Schimmelpilzschaden liegt hier sofort eine Belastungssituation vor. Auftreten können Enterobakterien (z.B. E.coli, Salmonellen, Clostridien, Klebsiellen u.a.), Viren (z.B. Enteroviren, Rotaviren, Hepatitis A-Viren u.a.) und z.B. Pilze. Bei der Sanierung müssen zwingend die gesundheitlichen Gefährdungen auf Grund bakterieller und/oder virologischer Belastungen ausgeschlossen werden. Die technischen Richtlinien für die Exposition von Arbeitnehmern gehen bei fäkalhaltigem Abwasser immer von einer Einstufung nach BIO II aus - das heißt, es sind besondere Schutzmaßnahmen bei der Sanierung zu berücksichtigen.  Nach unserer Erfahrung bedeutet dies, dass kontaminierte Einrichtungsgegenstände und belastetes Baumaterial ausgetauscht und entsorgt werden müssen. Eine technische Trocknung (z.B. von durchfeuchtetem Estrich oder Putz) reicht nicht aus, um eine Gesundheitsgefährdung für die Bewohner auszuschließen. Eine fachgerechte, zuverlässige Dekontamination (z.B. Sterilisation bei 121�C für 20 min, längere Begasung mit Desinfektionsmittel oder Tränkung mit Desinfektionsmittel) wird nur in den seltensten Fällen möglich und wirtschaftlich sein. Zusätzlich kann nicht garantiert werden, dass die Verfahren erfolgreich sind. Selbst nach dem Abtrocknen können Bakterien und Viren über den Luftweg übertragen werden.  DomoLytik Institut für Gebäude- und Innenraumanalytik GmbH
Kontakt aufnehmen
Schimmelpilze und Bakterien in Klimaanlagen
Waren Raumlufttechnische Anlagen (RLT) und Klimaanlagen in unseren Breiten in der Vergangenheit fast nur im gewerblichen Bereich (Bürogebäude und Geschäfte) installiert, werden sie seit ca. 1990 verstärkt auch in Privathaushalten installiert. Dies hat zwei Gründe: 1. Um den niedrigen Jahreswärmebedarf von Niedrigenergiehäusern und besonders Passivhäusern zu erreichen, muss schon zwingend eine zentrale Lüftungsanlage mit Wärmerückgewinnung eingebaut werden. Zusätzlich werden noch Erdwärmetauscher installiert, um auch im Sommer angenehme Raumtemperaturen zu erreichen. Bei diesen Einbauten darf jedoch nicht vergessen werden, dass diese Geräte einen zusätzlichen Wartungsbedarf haben. Werden Filter und Geräte nicht regelmäßig ausgetauscht bzw. gereinigt, ist mikrobielle Verkeimung nur eine Frage der Zeit. Besonders die beliebten Erdwärmetauscher sind dafür sehr empfindlich. Zusätzlich lassen hier selbst kleine Planungs- oder Ausführungsfehler das mikrobiologische Wachstum sprießen. Bei Verdacht hilft eine Luftmessung das Problem einzugrenzen. 2. Die zunehmend wärmeren Sommermonate führen auch im Gebäudebestand zu verstärkter Anstrengung nach angenehmer Temperierung. Klimasplit- oder Monogeräte sollen es richten und für angenehme Kühle sorgen. Auch hier gilt: Diese Geräte sind nicht wartungsfrei! Wasser und Staub bilden einen hervorragenden Nährboden für ein mikrobiologisches Kleinklima. Zusätzlich kann die unsachgemäße Verlegung des Kondensatschlauches (durch den Schlauch können bei Volllast mehrere Liter Wasser am Tag laufen) ein ausgeprägtes Schimmelpilzproblem verursachen, wie wir mehrfach feststellen konnten.  In einer ausführlichen Beratung klären wir gerne über Gesundheitsrisiken und Problemzonen der entsprechenden Anlagen auf. Es werden hygienische Grundlagen vermittelt und über sinnvolle Kontrollintervalle informiert. Bei Verdacht helfen Luftmessungen das Problem einzugrenzen und zu lösen.  DomoLytik Institut für Gebäude- und Innenraumanalytik GmbH
Kontakt aufnehmen
Befall mit Holz zerstörenden Pilzen
Schimmelpilze wachsen auf Holz nur oberflächlich. Sie dringen nicht tiefer in die Holzstruktur ein und beeinträchtigen damit nicht die Holzstruktur und die statische Standsicherheit, können jedoch bei den Bewohnern ernste Gesundheitsgefahren auslösen. Bei den Holz zerstörenden Pilzen ist die Ausgangslage umgekehrt: Während sie für die menschliche Gesundheit weitgehend unkritisch sind, können sie durch die Schädigung der Gebäudestruktur zu ernsten statischen Problemen führen.  Wie bei Schimmelpilzbefall ist der Hauptfaktor für einen Befall mit Holz zerstörenden Pilzen immer eine zu hohe Feuchtigkeit. In trockenem Holz können Pilze nicht wachsen, sinkt jedoch der Feuchtigkeitsgehalt von befallenem Holz ab, können Holz zerstörende Pilze in eine Trockenstarre verfallen, aus der sie durch erneute Feuchtigkeitszufuhr wieder zu aktivem Wachstum finden. Auch gebildete Sporen können über viele Jahre keimfähig bleiben und nach Feuchtigkeitszufuhr mit dem Auswachsen des Myzels beginnen. Zu den Holz zerstörenden Pilzen gehören Porlinge (verursachen Weißfäule), Blättlinge sowie Hausschwamm, Kellerschwamm und Porenschwamm (verursachen Braunfäule). Den größten Schaden richtet dabei der "echte" Hausschwamm an, der auch die umfangreichsten Sanierungsmaßnahmen nach sich zieht. In einzelnen Bundesländern (nicht in NRW!) ist der Befall mit echtem Hausschwamm und dessen abgeschlossene Bekämpfung der Bauaufsichtsbehörde anzuzeigen. Haben Sie den Verdacht auf Befall mit Holz zerstörenden Pilzen, ziehen Sie bitte umgehend einen Fachmann zu Rate. DomoLytik, Institut für Gebäude- und Innenraumanalytik bestimmt die Ursache und Art des Befalls, grenzt die geschädigten Stellen ein und hilft Ihnen die Ursache nachhaltig zu beseitigen.  DomoLytik Institut für Gebäude- und Innenraumanalytik GmbH
|
|
|
Gesundheitliche Beeinträchtigungen durch chemische Schadstoffe
Bis Anfang der 80er-Jahre waren chemische Innenraumschadstoffe noch kein großes Thema. Durch die massive Verwendung von Bioziden und Holzschutzmitteln zeigten sich jedoch in der Folge massive Gesundheitsbeschwerden der Bewohner. Nach juristischer "Aufarbeitung" in Musterprozessen gegen Hersteller von Holzschutzmitteln wurden in der Folge die gebräuchlichsten Chemikalien auf Grund ihrer Toxizität verboten (Lindan, PCP u.a.). Auch die zunehmende Sensibilisierung für die Gesundheitsgefahren durch Asbest und PCB führte in der Folge zum Austausch des Materials gegen unbedenkliche Stoffe. Im Falle der künstlichen Mineralfasern (KMF) mussten auch diese Ersatzstoffe nochmals modifiziert werden, um Gesundheitsgefahren auszuschließen. Im Moment befinden wir uns im nächsten Schritt der Diskussion. Gebäude werden auf Grund der gültigen Energieeinsparverordnung immer luftdichter konstruiert und ausgeführt. Durch die fehlende natürliche Zwangslüftung reichern sich flüchtige Chemikalien in der Raumluft damit zu höheren Konzentrationen an und können ebenfalls Gesundheitsbeschwerden auslösen. Zusammengefasst wird dies unter dem Begriff Sick-Building-Syndrome (SBS). Verantwortlich dafür sind z.B. flüchtige organische Verbindungen, die als Lösungsmittel etwa in Farben und Lacken Verwendung finden. Aber auch die eigentlich schon abgeschlossene Diskussion um Formaldehyd zum Beispiel aus Holzwerkstoffen beginnt durch die steigenden Innenraumkonzentration auf Grund der geforderten Luftdichtheit der Gebäude wieder von Neuem. DomoLytik, Institut für Gebäude- und Innenraumanalytik GmbH führt Messungen und Analysen nach der VDI-Richtlinie 4300 durch. Bei Verdacht auf chemische Schadstoffe werden wir eine schnelle orientierende Untersuchung z.B. mittels Prüfröhrchen anbieten, an die sich im Falle einer Belastungssituation eine detailliertere Laboranalytik anschließen kann.  DomoLytik Institut für Gebäude- und Innenraumanalytik GmbH
Kontakt aufnehmen
Biozide (Holzschutzmittel, Insektizide, Fungizide, Herbizide)
Biozide sind in der Schädlingsbekämpfung eingesetzte Chemikalien oder Biochemikalien. Sie sind dazu bestimmt, auf chemischem oder biologischem Wege "Schadorganismen" (also Organismen, die der Mensch an dieser Stelle und/oder an diesem Ort nicht dulden möchte) zu zerstören, abzuschrecken und unschädlich zu machen. Die Eigenschaft, lebende Organismen abzutöten oder zumindest in ihrer Lebensfunktion einzuschränken, birgt auch das Risiko unerwünschter Wirkungen und Gefahren für die menschliche Gesundheit. Die in der Vergangenheit vielfach verwendeten Holzschutzmittel sowie Schädlingsbekämpfungsmittel sind ein häufiger Grund für Innenraumbelastungen in Wohnungen. Holzschutzmittelwirkstoffe  In den letzten Jahrzehnten wurden eine Vielzahl von Holzschutzmittelwirkstoffen verwendet. Das bekannteste Holzschutzmittel Pentachlorphenol (PCP) ist seit 1989 in Deutschland verboten. Bis in die frühen 80er-Jahre wurden jedoch häufig mit Holz ausgebaute Innenräume mit PCP-haltigen Holzschutzmitteln behandelt. Dies kann auch heute noch zu einer nachweisbaren Innenraumbelastung führen. Nachweismöglichkeiten sind - in der Raumluft (aktive Probenahme) - im Holz, z.B. als Nachweis oder Beurteilung der Sanierungsbedürftigkeit - im Hausstaub - in Textilien oder Teppichböden. Die Probennahme wird durch unsere Mitarbeiter in Anlehnung an die Richtlinien der Berufsgenossenschaften (BIA-Richtlinien) und die einschlägige Normen (VDI-Richtlinien) durchgeführt. Schädlingsbekämpfungsmittel Chlorinsektizide, Phosphorsäureester (z.B. Dichlorfos, Chlorpyrifos) und Pyrethroide (z.B. Permethrin) finden in Innenräumen als Schädlingsbekämpfungsmittel vielfältige Verwendung. Viele besitzen toxische bzw. neurotoxische Eigenschaften. In der Regel werden sie von Kammerjägern und auch Laien eingesetzt. Nach einer Schädlingsbekämpfungsmaßnahme können über einen langen Zeitraum erhöhte Biozidrückstände im Staub und der Innenraumluft auftreten.  DomoLytik Institut für Gebäude- und Innenraumanalytik GmbH
Kontakt aufnehmen
Formaldehyd
Formaldehyd ist ein Gas, das Augen und Schleimhäute reizt. Es steht im begründeten Verdacht, krebserregend zu sein (MAK-Liste, Maximale-Arbeitsplatz-Konzentration). Quellen von Formaldehyd in Innenräumen sind: - Leime, Kleber auf Formaldehydbasis in Holzspanplatten - Möbel, Türen, Böden, Wand- und Deckenverkleidung aus Holzspanplatten - Teppiche - Tabakrauch Seit vielen Jahrzehnten werden Holzspanplatten im Möbelbau und im Innenausbau als Ersatz für die deutlich teureren Massivholzbretter eingesetzt. Grundmaterial sind Holzspäne, die aus Holzresten, Durchforstungsholz und Altholz gemahlen werden. Durch Zugabe von Bindemitteln (Klebern) können die Späne zu formstabilen Platten gepresst (Pressspanplatten) werden. Für diese Bindemittel werden in über 90% der Platten Kunstharze verwendet, die über die Produktlebensdauer der Platten Formaldehyd abgeben. Erst nach Zerfall der Platten (nach 30-50 Jahren) ist die Gefahr vorüber. Pressspanplatten werden in mehrere Emissionsklassen eingeteilt, die Auskunft über die Ausgleichskonzentration und damit über die Formaldehydabgabe an die Raumluft geben: F0= formaldehydfrei (z.B. zementgebundene Platten) E1= Ausgleichskonzentration Formaldehyd unter 0,1 ppm (part per million) E2= Ausgleichskonzentration Formaldehyd zwischen 0,1 und 1,0 ppm E1= Ausgleichskonzentration Formaldehyd über 1,0 ppm Das RAL-Umweltzeichen erhalten nur Platten mit einer Ausgleichskonzentration von unter 0,05 ppm. In Kombination mit geringen Luftwechselraten bei luftdichten Gebäudehüllen können sich aber auch hier wieder Innenraumkonzentrationen einstellen, die zu Gesundheitsrisiken führen. Für Formaldehyd sind Grenzwerte für die Innenraumbelastung festgelegt worden. Die Weltgesundheitsorganisation WHO sieht unterhalb einer Belastung von 0,042 ppm keinen oder wenig Grund zur Besorgnis. Als Besorgnis erregend stuft sie Belastungen ein, die 0,083 ppm überschreiten. Ähnlich das Bremer Umweltinstitut: Wenn eine "deutliche Belastung" von 0,05 bis 0,08 ppm vorliegt, sollten die Quellen ermittelt und mittelfristig entfernt werden. Eine hohe Konzentration von mehr als 0,08 ppm mache eine Sanierung erforderlich. Die stärkste Formaldehydquelle in Innenräumen ist übrigens Zigarettenrauch!  DomoLytik Institut für Gebäude- und Innenraumanalytik GmbH
Kontakt aufnehmen
Flüchtige organische Verbindungen (VOC)
VOC (Volatile Organic Compounds, also flüchtige organische Verbindungen) werden aus vielen Materialien der Bau-, Renovierungs- und Gebäudeausstattung abgegeben. Hierzu zählen beispielsweise die leicht flüchtigen Lösungsmittel in Lacken, Farben und Klebern, die mit dem Austrocknen bzw. Aushärten in die Raumluft übergehen. In Neubauten bzw. frisch renovierten Gebäuden finden sich immer erhöhte Konzentrationen, die durch häufiges Lüften auf niedrigere Konzentrationen reduziert werden können. Schwerer flüchtige organische Substanzen aus (Dispersions-)Farben und Weichmachern aus Kunststoffen sind für das sogenannte "Fogging" in Wohnungen verantwortlich. Anzeichen kann z.B. eine auffällige Graufärbung an den Stellen mit niedriger Oberflächentemperatur sein.  DomoLytik Institut für Gebäude- und Innenraumanalytik GmbH
Kontakt aufnehmen
Flüchtige organische Verbindungen mikrobiellen Ursprungs (MVOC)
MVOC (Microbial Volatile Organic Compounds) sind bevorzugt bei Feuchtigkeitsschäden des Gebäudes in der Raumluft anzutreffen. Bei ihnen handelt es sich um Stoffwechselprodukte von Bakterien und Schimmelpilzen, die zum Teil für einzelne Schimmelarten charakteristisch sind und z.B. den muffig-moderigen Geruch ausmachen. MVOC können sich in der Raumluft auch bei versteckten Schimmelpilzschäden finden. Sie liefern einen Hinweis, jedoch ist ihr Auftreten nicht zwingend mit Schimmelpilzschäden assoziiert. Ein Schimmelpilzspürhund kann mit Hilfe von ausgasenden MVOC die Schimmelpilzquelle identifizieren.  DomoLytik Institut für Gebäude- und Innenraumanalytik GmbH
Kontakt aufnehmen
Künstliche Mineralfasern (KMF)
Zu den KMF zählt man u.a. Glas- und Steinfasern. Hergestellt werden sie aus Glas- oder Steinschmelzen, die durch sehr feine Düsen gepresst werden. Zusammen mit Bindemitteln werden KMF zu Platten verarbeitet, die auf Grund ihres hohen Luftanteils ein gutes Wärmedämmverhalten aufweisen und bei der Wärme- und Schalldämmung von Gebäuden eine breite Verwendung finden. In den 70er-Jahren wurde nachgewiesen, dass Asbest (eine natürliche Mineralfaser!) auf Grund ihrer Fasergeometrie nachweislich Lungenkrebs verursacht. Wegen ihrer ähnlichen geometrischen mikroskopischen Struktur gerieten auch die KMF in Verdacht. In der Folge kam eine zweite Generation KMF auf den Markt, deren Fasern eine größere Biolöslichkeit aufweisen. Dazu muss der Kanzerogenitätsindex Ki >= 40 liegen. Dies wird erreicht, wenn der Filamentdurchmesser größer als 3 µm ist, also die Fasern nicht lungengängig sind oder der Nachweis einer ausreichend hohen Biolöslichkeit im Tierversuch erbracht werden kann. Dabei bezieht sich die Biolöslichkeit auf die Halbwertzeit der KMF im Lungengewebe, die unter 40 Tagen liegen muss. Hierbei bedeutet eine hohe Biolöslichkeit eine niedrige Halbwertzeit. Biopersistente Fasern, also Fasern mit geringer Biolöslichkeit, darunter fallen Glas- oder Steinwollen, die vor ca. 1995 hergestellt wurden, dürfen nicht mehr verkauft werden. Sie sind jedoch in vielen Altbauten noch verbaut. Vor Sanierungs- oder Abbrucharbeiten sind deshalb entsprechende Materialanalysen durchzuführen. Bei positivem Befund - Ki-Index < 40 - sind die entsprechenden Arbeitsschutzmaßnahmen zu berücksichtigen. Bei vorhandener und intakter innenseitiger Dampfsperrfolie ist es jedoch nicht notwendig, die älteren Dämmstoffe zu entfernen. Dabei würden viele Fasern freigesetzt und die Raumluft entsprechend hoch belastet werden. Räume, in denen Mineralfaserdämmstoffe nicht mit Aluminium- oder Kunststofffolie abgedeckt sind, also Fasern der Raumluft frei zugänglich vorliegen, sollten dringend saniert werden.
Vorteile von KMF sind ihre Beständigkeit gegen Schimmel, Pilze und Insekten.  DomoLytik Institut für Gebäude- und Innenraumanalytik GmbH
Kontakt aufnehmen
Asbest
Asbest wurde bis in die 70er-Jahre auch "Wunderfaser" genannt, weil es eine große Festigkeit besitzt und hitzebeständig ist. Diese Hitzebeständigkeit führte dazu, dass Spritzasbest zum vorbeugenden Brandschutz vor allem bei Stahlskelettbauten eingesetzt wurde. Aufgrund der Kanzerogenität (z.B. Auslösen von Lungen- und Rippenfelltumoren) der lungengängigen Asbestfasern, ist der Einsatz von Asbest heute in vielen Ländern verboten, unter anderem in der ganzen EU. Asbest stellt heute primär ein Entsorgungsproblem dar, kann aber nach Rückfrage mit den zuständigen Stellen bei Privatpersonen meist staubdicht verpackt auf normalen Hausmülldeponien entsorgt werden. Bei der Beurteilung ist die Erkennung von Spritzasbest fast immer ein Anzeichen für baldige Sanierungsmaßnahmen. Unproblematischer ist zementgebundenes Asbest, das in Plattenform bis Ende der 80er-Jahre u.a. zur Dach- und Fassadenverkleidung eingebaut wurde. Sind die Platten nicht verwittert und sind keine offenen Fasern zu erkennen, muss nicht notwendigerweise sofort saniert werden.   DomoLytik Institut für Gebäude- und Innenraumanalytik GmbH
Kontakt aufnehmen
Polychlorierte Biphenyle (PCB)
Polychlorierte Biphenyle sind toxische und krebserregende Chemikalien, die bis in die 80er-Jahre vor allem als Weichmacher in Dichtmassen und Kunststoffen, in Transformatoren, elektrischen Kondensatoren und als Hydraulikflüssigkeit verwendet wurden. PCB zählen auf Grund ihrer geringen biologischen Abbaubarkeit und ihrer langen Persistenz in der Umwelt zu den zwölf als "dreckiges Dutzend" bekannten organischen Giftstoffen, welche weltweit verboten wurden.  In der Zeit von 1960 bis 1989 wurden PCB als Weichmacher dem Dichtungsmaterial zwischen Betonbauteilen (Dehnungsfugen) zugesetzt. PCB gasen über längere Zeiträume aus und belasten die Raumluft in Gebäuden. Vor allem im öffentlichen Gebäudebestand fand in den letzten Jahren ein Austausch der Dichtmassen statt, wenn PCB nachgewiesen wurden. PCB können sowohl in Materialproben als auch in der Raumluft analytisch nachgewiesen werden.  DomoLytik Institut für Gebäude- und Innenraumanalytik GmbH
Kontakt aufnehmen
Feinstaub
In den letzten Jahren wurden massive Anstrengungen unternommen, den Feinstaubgehalt der Außenluft abzusenken. Die Diskussion um Fahrverbote ist noch nicht abgeschlossen. Doch liegt in Wohn-, aber auch in öffentlichen Gebäuden die Belastung mit Feinstaub oft doppelt so hoch wie im Freien. Da der Mensch über 80% seiner Zeit in geschlossenen Räumen verbringt, hat die schlechte Luft im Inneren eine weitaus größere gesundheitliche Bedeutung. Untersuchungen in Haushalten zeigten, dass in jeder dritten Wohnung die Konzentration über 50 Mikrogramm Feinstaub je Kubikmeter Luft liegt. Dieser Grenzwert darf im Freien lediglich an 35 Tagen im Jahr überschritten werden. Es gibt sogar Wohnungen, in denen an jedem Tag im Jahr mehr Staub in der Luft schwebt, als in der Außenluft zulässig. Der Innenraum kommt deshalb bei der gegenwärtigen Feinstaubdiskussion viel zu kurz. In Schulen findet sich ein ähnliches Bild. Untersuchungen des Landesamtes für Arbeitsschutz in Berlin im Juni 2006 belegen, dass der Feinstaub in vierzig Berliner Schulen in fast allen Klassenzimmern über dem Grenzwert von 50 Mikrogramm je Kubikmeter Luft lag. Im Mittel war die Konzentration sogar doppelt so hoch wie in der Außenluft der unmittelbaren Umgebung der Schulen. Besonders "dicke Luft" herrscht in Raucherwohnungen und in Büros. Hier wurden Messwerte bis zum 20-Fachen der Grenzwerte für Außenluft entdeckt. Der Feinstaub setzt sich aus für die Augen unsichtbaren Teilchen zusammen, die maximal einige tausendstel Millimeter (Mikrometer) groß sind, teilweise aber auch nur Dimensionen von einigen milliardstel Millimetern (Nanometer) aufweisen. Vor allem die sehr kleinen Vertreter dringen tief in die Lunge vor. Sie gelangen über die Lungenbläschen ins Blut und in weitere Organe. Der Feinstaub reizt und schädigt auf diese Weise sowohl die Lunge als auch entfernt liegendes Körpergewebe. Der Feinstaub erhöht eindeutig das Risiko für Infarkte und Herz-Kreislauf-Erkrankungen. Extrembeispiel ist hier sicherlich die sogenannte Staublunge bei Bergarbeitern, die zeitlebens einer hohen Feinstaubbelastung ausgesetzt waren. Besonders deutlich reagieren Allergiker und Asthmatiker nach dem Einatmen der Partikel. Wahrscheinlich verhält sich der Feinstaub so aggressiv, weil sich viele Fremdstoffe an die kleinen Partikel heften können. So klammern sich in Wohnungen Allergene von der Hauskatze ebenso wie Chemikalien aus Teppichen (z.B. Pyrethroide), Computern (Flammschutzmittel) oder Möbeln an die Teilchen. Selbst eigentlich nicht luftgängige Substanzen können so den Weg in die Raumluft finden. Bei Kerzen und Kaminfeuern lagern sich krebserregende Verbrennungsrückstände an die Partikel an. Je nach Lage der Wohnung speist sich der Staub im Inneren etwa zur Hälfte aus dem Feinstaub von draußen. Daneben verschlechtern Zigaretten, Kerzen und offene Kamine die Luft in den eigenen vier Wänden. Auch beim Kochen und Braten werden Partikel in die Luft geschleudert, die sich jedoch mit Dunstabzugshauben absaugen lassen. Besondere Bedeutung für die Feinstaubbelastung in Bürogebäuden haben Kopierer und Drucker, vor allem Laserdrucker.  DomoLytik Institut für Gebäude- und Innenraumanalytik GmbH
Kontakt aufnehmen |
|
|
Beeinträchtigung durch physikalische Einflüsse (Strahlung) in Gebäuden
Wie bei chemischen und biologischen Schadstoffen und Beeinträchtigungen können wir auch physikalische Effekte, die auf uns einwirken, nur zum Teil wahrnehmen. Strahlung können wir als Licht sehen oder Wärme fühlen, beides ist lebensnotwendig. Der größte Teil der Strahlung lässt sich vom Menschen jedoch nur mit technischen Hilfsmitteln (z.B. Messinstrumenten) wahrnehmen. Die ultraviolette Strahlung des Sonnenlichts beispielsweise kann Hautschädigungen wie Sonnenbrand auslösen oder im Extremfall Hautkrebs verursachen. Auch ionisierende Strahlung wie Röntgenstrahlung, radioaktive Strahlung beim Zerfall instabiler Atome oder kosmische Strahlung aus dem All ist nicht wahrnehmbar und kann auf Grund der höheren Eindringtiefe ähnliche Erkrankungen auch in tiefer liegenden inneren Organen auslösen.  Durch elektromagnetische Wechselfelder hervorgerufene Strahlung wird für den Betrieb von technischen Einrichtungen wie z.B. Mobilfunk, Radio, Fernsehen, Radaranlagen, WLAN, GPS-Navigation oder Mikrowelle erzeugt. Ob und welche Gesundheitsrisiken bestehen, wird zur Zeit sehr kontrovers diskutiert.   DomoLytik Institut für Gebäude- und Innenraumanalytik GmbH
Kontakt aufnehmen
Radioaktive (ionisierende) Strahlung
Allgemein Zur ionisierenden Strahlung zählt die ultraviolette Strahlung, Röntgen- und Gammastrahlung sowie Partikelstrahlung wie z.B. Alpha-, Beta- und Neutronenstrahlung. Ionisierende Strahlung ist wissenschaftlich nachgewiesen krebserregend und erbgutschädigend. Neben akuten kann es auch zu bleibenden Strahlenschäden kommen - sowohl bei den betroffenen Personen als auch den Nachkommen. Die Dosis ionisierender Strahlung sollte so gering wie möglich sein, ob es überhaupt einen unschädlich niedrigen Grenzwert gibt, ist wissenschaftlich umstritten. Eine Ausnahme bildet hier die ultraviolette Strahlung, die in geringer Dosis sogar lebensnotwendig ist und gegen die viele Organismen bei gemäßigter Belastung geeignete Abwehrstrategien entwickelt haben (z.B. Hautbräunung bei hellhäutigen Menschen). Ein großer Anteil der natürlichen ionisierenden Strahlung entsteht durch den radioaktiven Zerfall von Radon, der in Abhängigkeit der geographischen Lage große Schwankungsbreiten aufweist. Strahlung aus Baumaterialien In 90% aller Innenräume ist eine höhere Strahlenbelastung zu verzeichnen als im Freien. Neben der schon beschriebenen Belastung durch Radon spielen hier auch die verwendeten Baumaterialien (z.B. radioaktives Thorium in einzelnen Graniten oder uranhaltige Fliesenglasuren) eine große Rolle. Idealerweise sollten sich aber die Strahlenwerte außerhalb und innerhalb eines Gebäudes nicht unterscheiden. Wir messen und bewerten die in Ihrer Umgebung vorhandene ionisierende Strahlung und machen Ihnen, falls dies notwendig sein sollte, Vorschläge zu deren Reduzierung.  DomoLytik Institut für Gebäude- und Innenraumanalytik GmbH
Kontakt aufnehmen
Elektromagnetische Strahlung in Gebäuden
Die Installation und Verwendung bestimmter Technologien wie z.B. Radio, Fernsehen, Mobilfunk, WLAN, GPS-Navigation, aber auch Mikrowellengeräte führen in der Umgebung des Menschen zu elektromagnetischen Feldern. Im Gegensatz zu ionisierender Strahlung reicht die Energie dieser Strahlung nicht aus, um Atome und Moleküle elektrisch aufzuladen. Auf allen Ebenen (Medien, Wissenschaft und Politik) wird zur Zeit diskutiert, ob diese Strahlung im normalen Umgang gesundheitliche Folgen haben kann. Unterschiedliche Konzepte dienen hier zur Vorsorge. Wir messen die in Ihrer Umgebung vorhandenen elektrischen und magnetischen Felder und zeigen Ihnen, ob die nationalen und europäischen Grenzwerte eingehalten werden. Falls gewünscht, zeigen wir Ihnen auf biophysikalischer Basis, welche und wie geeignete Abschirmmaßnahmen diese Felder reduzieren können.  DomoLytik Institut für Gebäude- und Innenraumanalytik GmbH
Kontakt aufnehmen |
|

| Zentraler Post- & Probeneingang: 42555 Velbert Wilhelm-Teleu-Weg 34 Fon: 02052-800591 Fax: 02052-800592 |
Sekretariat: 40597 Düsseldorf Am Mönchgraben 56 Fon: 0211-41604-30 Fax: 0211-41604-36 |
Niederlassung: 87561 Oberstdorf Aurikelstraße 3 Fon: 08322-2188 Fax: 08322-2188 |

| Zentraler Post- & Probeneingang: 42555 Velbert Wilhelm-Teleu-Weg 34 Fon: 02052-800591 Fax: 02052-800592 |
Sekretariat: 40597 Düsseldorf Am Mönchgraben 56 Fon: 0211-41604-30 Fax: 0211-41604-36 |
Niederlassung: 87561 Oberstdorf Aurikelstraße 3 Fon: 08322-2188 Fax: 08322-2188 |

| Zentraler Post- & Probeneingang: 42555 Velbert Wilhelm-Teleu-Weg 34 Fon: 02052-800591 Fax: 02052-800592 |
Sekretariat: 40597 Düsseldorf Am Mönchgraben 56 Fon: 0211-41604-30 Fax: 0211-41604-36 |
Niederlassung: 87561 Oberstdorf Aurikelstraße 3 Fon: 08322-2188 Fax: 08322-2188 |

| Zentraler Post- & Probeneingang: 42555 Velbert Wilhelm-Teleu-Weg 34 Fon: 02052-800591 Fax: 02052-800592 |
Sekretariat: 40597 Düsseldorf Am Mönchgraben 56 Fon: 0211-41604-30 Fax: 0211-41604-36 |
Niederlassung: 87561 Oberstdorf Aurikelstraße 3 Fon: 08322-2188 Fax: 08322-2188 |
|
Gesundheitliche Beeinträchtigung durch biologische Ursachen
Bürogebäude und Innenräume können von unterschiedlichen biologischen Organismen befallen werden, die die Gesundheit der Nutzer beeinträchtigen. Am häufigsten ist Schimmelpilzbefall anzutreffen. Im Gegensatz zu Wohngebäuden sind hier offensichtliche und versteckte Wasserschäden (Rohrleitungen, Dachentwässerung) die häufigsten Ursachen. Den zweiten Platz nehmen Klimaanlagen ein, die bei Fehlern in der Konstruktion und Ausführung oder unzureichender Wartung eine Vielzahl von Pilzen und Bakterien beherbergen können. Auch können vorgeschaltete Erdwärmetauscher bei unsachgemäßer Konstruktion eine massive bakteriologische und Schimmelpilzbelastung aufweisen. Wir empfehlen folgende Vorgehensweise bei bestehender oder vermuteter mikrobiologischer Kontamination: 1. Kontaktaufnahme und Besprechung der Vorgehensweise mit allen Beteiligten 2. Begehung des Gebäudes durch einen unserer Sachverständigen für Innenraumanalytik zur Erkennung der Belastung, Dokumentation der Ergebnisse 3. wenn notwendig: Probennahme (Luft- und/oder Materialproben) mit anschließender Gattungs- und Artbestimmung im eigenen mikrobiologischen Labor. Schneller Vorbefund von Material- und Staubproben innerhalb 24 Stunden. Charakterisierung und Quantifizierung des Pilzes innerhalb weniger Tage* 4. Das Abschlussgutachten beantwortet die Fragen zur Ursache, Sanierungsdringlichkeit und langfristigen Abhilfemaßnahmen. 5. telefonische Beratung bei Unklarheiten und offenen Fragen *Bei Kontakt- und Luftproben bestimmen die unterschiedlichen Wachstumsgeschwindigkeiten der Schimmelpilze die Schnelligkeit der Analyse. Dieses Vorgehen garantiert eine schnelle Problemerkennung und hilft, wertvolle Zeit bei der Beseitigung der Ursachen zu sparen. Wir richten uns dabei u.a. streng nach den Vorgaben des A) Umweltbundesamtes, niedergelegt im "Leitfaden zur Vorbeugung, Untersuchung, Bewertung und Sanierung von Schimmelpilzwachstum in Innenräumen" von 2002, erstellt durch die Innenraumlufthygienekommission des Umweltbundesamtes, B) Landesgesundheitsamtes Baden-Württemberg, niedergelegt im Leitfaden "Schimmelpilze in Innenräumen - Nachweis, Bewertung, Qualitätsmanagement" von Dezember 2004.  DomoLytik Institut für Gebäude- und Innenraumanalytik GmbH
Kontakt aufnehmen
Schimmelpilze in Innenräumen
Schimmelpilze sind Teil unserer natürlichen Umwelt. Im Laufe der Evolution haben sich die Pilze über Millionen von Jahren ideal darauf angepasst, auf vorhandener Biomasse zu wachsen. Dabei sind sie sehr anspruchslos, es können praktisch alle Arten organischen Gewebes (z.B. Holz, Papier, aber auch Weichmacher aus Kunststoffen) als Substrat dienen. Die Biomasse wird dabei zersetzt und zu anorganischen Substanzen abgebaut, die als wichtige Nährstoffgrundlage für andere Lebewesen wie z.B. Pflanzen dienen. Schimmelpilze sind also ideale "Recycler". In Innenräumen sind Schimmelpilze dagegen zu Recht höchst unerwünscht. Schimmelpilze setzen zu ihrer Vermehrung Millionen von winzigen Sporen frei, die die Luft kontaminieren, die wir einatmen. Im Gegensatz zu Wohngebäuden ist ein Schimmelpilzbefall in Bürogebäuden sehr häufig durch eindringendes Wasser aus Rohrleitungen oder undichter Dachentwässerung verursacht.  Wird die Schadensursache nicht umgehend beseitigt und der Schaden technisch getrocknet, kann sich schon innerhalb weniger Tage eine massive, sichtbare mikrobiologische Belastung durch Schimmelpilze ergeben. Tückischer sind versteckte Schimmelpilzschäden, die sich in Zwischenwänden (mit Gipskarton beplanktes Ständerwerk) oder in abgehängten Decken entwickeln und die erst aufgefunden werden, nachdem die Nutzer über die nachfolgenden Beschwerden klagen: - Allergien (Schimmelpilze sind das dritthäufigste Allergen nach Pollen und Milben.) - Atemwegserkrankungen (Husten, Schnupfen, Entzündungen der Nebenhöhlen) - Augenentzündungen und Schleimhautreizungen - Kopfschmerzen - Vergiftungen (durch Mykotoxinen, z.B. Stachbotrys chartarum, Aspergillus flavus) - Infektionen (sehr selten bei gesunden Menschen) Häufig können die Ursachen dieser Erkrankungen mangels fehlender Innenraumanalytik nicht erkannt und somit nur Symptome und nicht Ursachen bekämpft werden. Erfahrungsgemäß stellen Schimmelpilze in Bürogebäuden ein besonderes Gefährdungspotenzial dar für: - Personen mit eingeschränkter Lungenfunktion - immunsupprimierte Personen - immungeschwächte Personen - Allergiker  DomoLytik Institut für Gebäude- und Innenraumanalytik GmbH
Kontakt aufnehmen
Schimmelpilze und Bakterien in Raumlufttechnischen Anlagen (RLT) und Klimaanlagen
Allgemein RLT und Klimaanlagen machen das Leben in der Regel angenehmer. Im Sommer sollen sie auf angenehme Temperaturen kühlen, aber es darf nicht zu kalt sein. Im Winter hingegen muss die gleiche Anlage eine angenehme Temperatur erzeugen, aber nicht zu trockene Luft produzieren - eine technische Hochleistung und ein Spagat zwischen zweierlei Temperaturfeldern und Aufgabengebieten. Raumlufttechnische Anlagen können jedoch auch Befindlichkeitsstörungen, gesundheitliche Beeinträchtigungen, leichte oder sogar ernsthafte Erkrankungen der Atemwege auslösen. Die Ursachen hierfür liegen (neben Planungsmängeln bei älteren Anlagen) hauptsächlich in ungenügender oder fehlerhafter Wartung. Beeinträchtigung durch RLT Objektive Studien zeigen, dass ein großer Anteil der Ursachen für Gesundheitsbeschwerden in Innenräumen mit Klima- und Lüftungsanlagen tatsächlich durch diese bedingt ist.
Beschwerden Gesundheitsbeschwerden durch mangelhafte RLT- und Klimaanlagen sind: - häufige Infektionen der Atemwege - Auftreten undefinierter Allergien - Befindlichkeitsstörungen (Müdigkeit, Übelkeit, Kopfschmerzen, Schwindel, Abgeschlagenheit, Konzentrationsschwäche, Temperaturmissempfinden) - Gelenkschmerzen, Migräne, Haut- und Schleimhautirritationen Es ergeben sich verminderte Arbeitsleistung und krankheitsbedingte Fehltage. Schätzungen in den USA zufolge liegt die Anzahl der dadurch verursachten Fehltage bei 150 Millionen pro Jahr liegt. Runtergerechnet auf Deutschland ergibt sich hier immer noch ein deutlich zweistelliger Millionenwert und damit ein halber bis ganzer Fehltag pro Mitarbeiter und Jahr. Im Vergleich dazu sind die Kosten für entsprechende Maßnahmen zur Erfüllung der Anforderungen an die Hygiene und deren dauerhafte Sicherung durch entsprechende Kontrollen gering. Abhilfe 50% aller hier aufgeführten Beschwerden lassen sich auf einen Hygienemangel der RTL- und Klimaanlagen zurückführen. Eine entsprechende Hygienekontrolle der Zuluft hilft weiter, erkennt die Ursache und zeigt Wege zur Abhilfe auf. In einer ausführlichen Beratung klären wir gerne über Gesundheitsrisiken und Problemzonen der entsprechenden Anlagen auf. Es werden hygienische Grundlagen vermittelt und über sinnvolle Kontrollintervalle informiert. Bei Verdacht helfen Luftmessungen, das Problem einzugrenzen und zu lösen.  DomoLytik Institut für Gebäude- und Innenraumanalytik GmbH
Kontakt aufnehmen |
|
|
Gesundheitliche Beeinträchtigungen durch chemische Schadstoffe
Bis Anfang der 80er-Jahre waren chemische Innenraumschadstoffe noch kein großes Thema. Durch die massive Verwendung von Bioziden und Holzschutzmitteln zeigten sich jedoch in der Folge massive Gesundheitsbeschwerden der Bewohner. Nach juristischer "Aufarbeitung" in Musterprozessen gegen Hersteller von Holzschutzmitteln wurden in der Folge die gebräuchlichsten Chemikalien auf Grund ihrer Toxizität verboten (Lindan, PCP u.a.). Auch die zunehmende Sensibilisierung für die Gesundheitsgefahren durch Asbest und PCB führte in der Folge zum Austausch des Materials gegen unbedenkliche Stoffe. Im Falle der künstlichen Mineralfasern (KMF) mussten auch diese Ersatzstoffe nochmals modifiziert werden, um Gesundheitsgefahren auszuschließen. Im Moment befinden wir uns im nächsten Schritt der Diskussion. Gebäude werden auf Grund der gültigen Energieeinsparverordnung immer luftdichter konstruiert und ausgeführt. Durch die fehlende natürliche Zwangslüftung reichern sich flüchtige Chemikalien in der Raumluft damit zu höheren Konzentrationen an und können ebenfalls Gesundheitsbeschwerden auslösen. Zusammengefasst wird dies unter dem Begriff Sick-Building-Syndrome (SBS). Verantwortlich dafür sind z.B. flüchtige organische Verbindungen, die als Lösungsmittel etwa in Farben und Lacken Verwendung finden. Aber auch die eigentlich schon abgeschlossene Diskussion um Formaldehyd zum Beispiel aus Holzwerkstoffen beginnt durch die steigenden Innenraumkonzentration auf Grund der geforderten Luftdichtheit der Gebäude wieder von Neuem.  DomoLytik Institut für Gebäude- und Innenraumanalytik GmbH
Kontakt aufnehmen
Biozide (Holzschutzmittel, Insektizide, Fungizide, Herbizide)
Biozide sind in der Schädlingsbekämpfung eingesetzte Chemikalien oder Biochemikalien. Sie sind dazu bestimmt, auf chemischem oder biologischem Wege "Schadorganismen" (also Organismen, die der Mensch an dieser Stelle und/oder an diesem Ort nicht dulden möchte) zu zerstören, abzuschrecken und unschädlich zu machen. Die Eigenschaft, lebende Organismen abzutöten oder zumindest in ihrer Lebensfunktion einzuschränken, birgt auch das Risiko unerwünschter Wirkungen und Gefahren für die menschliche Gesundheit. Die in der Vergangenheit vielfach verwendeten Holzschutzmittel sowie Schädlingsbekämpfungsmittel sind ein häufiger Grund für Innenraumbelastungen in Bürogebäuden. Holzschutzmittelwirkstoffe  In den letzten Jahrzehnten wurden eine Vielzahl von Holzschutzmittelwirkstoffen verwendet. Das bekannteste Holzschutzmittel Pentachlorphenol (PCP) ist seit 1989 in Deutschland verboten. Bis in die frühen 80er-Jahre wurden jedoch häufig mit Holz ausgebaute Innenräume mit PCP-haltigen Holzschutzmitteln behandelt. Dies kann auch heute noch zu einer nachweisbaren Innenraumbelastung führen. Nachweismöglichkeiten sind - in der Raumluft (aktive Probennahme ) - im Holz, z.B. als Nachweis oder Beurteilung der Sanierungsbedürftigkeit - im Hausstaub - in Textilien oder Teppichböden. Die Probennahme wird durch unsere Mitarbeiter in Anlehnung an die Richtlinien der Berufsgenossenschaften (BIA-Richtlinien) und die einschlägige Normen (VDI-Richtlinien) durchgeführt. Schädlingsbekämpfungsmittel Chlorinsektizide, Phosphorsäureester (z.B. Dichlorfos, Chlorpyrifos) und Pyrethroide (z.B. Permethrin) finden in Innenräumen als Schädlingsbekämpfungsmittel vielfältige Verwendung. Viele besitzen toxische bzw. neurotoxische Eigenschaften. In der Regel werden sie von Kammerjägern und auch Laien eingesetzt. Nach einer Schädlingsbekämpfungsmaßnahme können über einen langen Zeitraum erhöhte Biozidrückstände im Staub und der Innenraumluft auftreten.  DomoLytik Institut für Gebäude- und Innenraumanalytik GmbH
Kontakt aufnehmen
Formaldehyd
Formaldehyd ist ein Gas, das Augen und Schleimhäute reizt. Es steht im begründeten Verdacht, krebserregend zu sein (MAK-Liste, Maximale-Arbeitsplatz-Konzentration). Quellen von Formaldehyd in Innenräumen sind: - Leime, Kleber auf Formaldehydbasis in Holzspanplatten - Möbel, Türen, Böden, Wand- und Deckenverkleidung aus Holzspanplatten - Teppiche - Tabakrauch. Seit vielen Jahrzehnten werden Holzspanplatten im Möbelbau und im Innenausbau als Ersatz für die deutlich teureren Massivholzbretter eingesetzt. Grundmaterial sind Holzspäne, die aus Holzresten, Durchforstungsholz und Altholz gemahlen werden. Durch Zugabe von Bindemitteln (Klebern) können die Späne zu formstabilen Platten gepresst (Pressspanplatten) werden. Für diese Bindemittel werden in über 90% der Platten Kunstharze verwendet, die über die Produktlebensdauer der Platten Formaldehyd abgeben. Erst nach Zerfall der Platten (nach 30-50 Jahren) ist die Gefahr vorüber. Pressspanplatten werden in mehrere Emissionsklassen eingeteilt, die Auskunft über die Ausgleichskonzentration und damit über die Formaldehydabgabe an die Raumluft geben: F0= formaldehydfrei (z.B. zementgebundene Platten) E1= Ausgleichskonzentration Formaldehyd unter 0,1 ppm (part per million) E2= Ausgleichskonzentration Formaldehyd zwischen 0,1 und 1,0 ppm E1= Ausgleichskonzentration Formaldehyd über 1,0 ppm Das RAL-Umweltzeichen erhalten nur Platten mit einer Ausgleichskonzentration von unter 0,05 ppm. In Kombination mit geringen Luftwechselraten bei luftdichten Gebäudehüllen können sich aber auch hier wieder Innenraumkonzentrationen einstellen, die zu Gesundheitsrisiken führen. Für Formaldehyd sind Grenzwerte für die Innenraumbelastung festgelegt worden. Die Weltgesundheitsorganisation WHO sieht unterhalb einer Belastung von 0,042 ppm keinen oder wenig Grund zur Besorgnis. Als Besorgnis erregend stuft sie Belastungen ein, die 0,083 ppm überschreiten. Ähnlich das Bremer Umweltinstitut: Wenn eine "deutliche Belastung" von 0,05 bis 0,08 ppm vorliegt, sollten die Quellen ermittelt und mittelfristig entfernt werden. Eine hohe Konzentration von mehr als 0,08 ppm mache eine Sanierung erforderlich. Die stärkste Formaldehydquelle in Innenräumen ist übrigens Zigarettenrauch!  DomoLytik Institut für Gebäude- und Innenraumanalytik GmbH
Kontakt aufnehmen
Flüchtige organische Verbindungen (VOC)
VOC (Volatile Organic Compounds, also flüchtige organische Verbindungen) werden aus vielen Materialien der Bau-, Renovierungs- und Gebäudeausstattung abgegeben. Hierzu zählen beispielsweise die leicht flüchtigen Lösungsmittel in Lacken, Farben und Klebern, die mit dem Austrocknen bzw. Aushärten in die Raumluft übergehen. In Neubauten bzw. frisch renovierten Gebäuden finden sich immer erhöhte Konzentrationen, die durch häufiges Lüften auf niedrigere Konzentrationen reduziert werden können. Schwerer flüchtige organische Substanzen aus (Dispersions-)Farben und Weichmachern aus Kunststoffen sind für das sogenannte "Fogging" in Wohnungen verantwortlich. Anzeichen kann z.B. eine auffällige Graufärbung an den Stellen mit niedriger Oberflächentemperatur sein.  DomoLytik Institut für Gebäude- und Innenraumanalytik GmbH
Kontakt aufnehmen |
|

| Wärmedämmung der Außenhülle (Wände, Dach, Fenster, Keller) |
 |
| Optimierung der Anlagentechnik (Heizung, Kühlung, Beleuchtung) |
 |
| Energiegewinnung durch Solarthermie (Solarkollektoren, Photovoltaik) |
 |

| Zentraler Post- & Probeneingang: 42555 Velbert Wilhelm-Teleu-Weg 34 Fon: 02052-800591 Fax: 02052-800592 |
Sekretariat: 40597 Düsseldorf Am Mönchgraben 56 Fon: 0211-41604-30 Fax: 0211-41604-36 |
Niederlassung: 87561 Oberstdorf Aurikelstraße 3 Fon: 08322-2188 Fax: 08322-2188 |




| Zentraler Post- & Probeneingang: 42555 Velbert Wilhelm-Teleu-Weg 34 Fon: 02052-800591 Fax: 02052-800592 |
Sekretariat: 40597 Düsseldorf Am Mönchgraben 56 Fon: 0211-41604-30 Fax: 0211-41604-36 |
Niederlassung: 87561 Oberstdorf Aurikelstraße 3 Fon: 08322-2188 Fax: 08322-2188 |


| Zentraler Post- & Probeneingang: 42555 Velbert Wilhelm-Teleu-Weg 34 Fon: 02052-800591 Fax: 02052-800592 |
Sekretariat: 40597 Düsseldorf Am Mönchgraben 56 Fon: 0211-41604-30 Fax: 0211-41604-36 |
Niederlassung: 87561 Oberstdorf Aurikelstraße 3 Fon: 08322-2188 Fax: 08322-2188 |


| Zentraler Post- & Probeneingang: 42555 Velbert Wilhelm-Teleu-Weg 34 Fon: 02052-800591 Fax: 02052-800592 |
Sekretariat: 40597 Düsseldorf Am Mönchgraben 56 Fon: 0211-41604-30 Fax: 0211-41604-36 |
Niederlassung: 87561 Oberstdorf Aurikelstraße 3 Fon: 08322-2188 Fax: 08322-2188 |

| Zentraler Post- & Probeneingang: 42555 Velbert Wilhelm-Teleu-Weg 34 Fon: 02052-800591 Fax: 02052-800592 |
Sekretariat: 40597 Düsseldorf Am Mönchgraben 56 Fon: 0211-41604-30 Fax: 0211-41604-36 |
Niederlassung: 87561 Oberstdorf Aurikelstraße 3 Fon: 08322-2188 Fax: 08322-2188 |

| Zentraler Post- & Probeneingang: 42555 Velbert Wilhelm-Teleu-Weg 34 Fon: 02052-800591 Fax: 02052-800592 |
Sekretariat: 40597 Düsseldorf Am Mönchgraben 56 Fon: 0211-41604-30 Fax: 0211-41604-36 |
Niederlassung: 87561 Oberstdorf Aurikelstraße 3 Fon: 08322-2188 Fax: 08322-2188 |
 |

| Zentraler Post- & Probeneingang: 42555 Velbert Wilhelm-Teleu-Weg 34 Fon: 02052-800591 Fax: 02052-800592 |
Sekretariat: 40597 Düsseldorf Am Mönchgraben 56 Fon: 0211-41604-30 Fax: 0211-41604-36 |
Niederlassung: 87561 Oberstdorf Aurikelstraße 3 Fon: 08322-2188 Fax: 08322-2188 |
|
Schimmelpilze in Innenräumen Schimmelpilze sind Teil unserer natürlichen Umwelt. Im Laufe der Evolution haben sich die Pilze über Millionen von Jahren ideal darauf angepasst, auf vorhandener Biomasse zu wachsen. Dabei sind sie sehr anspruchslos, es können praktisch alle Arten organischen Gewebes (z.B. Holz, Papier, aber auch Weichmacher aus Kunststoffen) als Substrat dienen. Die Biomasse wird dabei zersetzt und zu anorganischen Substanzen abgebaut, die als wichtige Nährstoffgrundlage für andere Lebewesen wie z.B. Pflanzen dienen. Schimmelpilze sind also ideale "Recycler". In Innenräumen sind Schimmelpilze dagegen zu Recht höchst unerwünscht. Schimmelpilze setzen zu ihrer Vermehrung Millionen von winzigen Sporen frei, die die Luft kontaminieren, die wir einatmen. Im Gegensatz zu Wohngebäuden ist ein Schimmelpilzbefall in Bürogebäuden sehr häufig durch eindringendes Wasser aus Rohrleitungen oder undichter Dachentwässerung verursacht.  Wird die Schadensursache nicht umgehend beseitigt und der Schaden technisch getrocknet, kann sich schon innerhalb weniger Tage eine massive, sichtbare mikrobiologische Belastung durch Schimmelpilze ergeben. Tückischer sind versteckte Schimmelpilzschäden, die sich in Zwischenwänden (mit Gipskarton beplanktes Ständerwerk) oder in abgehängten Decken entwickeln und die erst aufgefunden werden, nachdem die Nutzer über die nachfolgenden Beschwerden klagen: - Allergien (Schimmelpilze sind das dritthäufigste Allergen nach Pollen und Milben.) - Atemwegserkrankungen (Husten, Schnupfen, Entzündungen der Nebenhöhlen) - Augenentzündungen und Schleimhautreizungen - Kopfschmerzen - Vergiftungen (durch Mykotoxinen, z.B. Stachbotrys chartarum, Aspergillus flavus) - Infektionen (sehr selten bei gesunden Menschen) Häufig können die Ursachen dieser Erkrankungen mangels fehlender Innenraumanalytik nicht erkannt und somit nur Symptome und nicht Ursachen bekämpft werden. Erfahrungsgemäß stellen Schimmelpilze in Bürogebäuden ein besonderes Gefährdungspotenzial dar für: - Personen mit eingeschränkter Lungenfunktion - immunsupprimierte Personen - immungeschwächte Personen - Allergiker  DomoLytik Institut für Gebäude- und Innenraumanalytik GmbH
Kontakt aufnehmen |
|
|
Schimmelpilze und Bakterien in Raumlufttechnischen Anlagen (RLT) und Klimaanlagen in Gewerbegebäuden Allgemein RLT und Klimaanlagen machen das Leben in der Regel angenehmer. Im Sommer sollen sie auf angenehme Temperaturen kühlen, aber es darf nicht zu kalt sein. Im Winter hingegen muss die gleiche Anlage eine angenehme Temperatur erzeugen, aber nicht zu trockene Luft produzieren - eine technische Hochleistung und ein Spagat zwischen zweierlei Temperaturfeldern und Aufgabengebieten. Raumlufttechnische Anlagen können jedoch auch Befindlichkeitsstörungen, gesundheitliche Beeinträchtigungen, leichte oder sogar ernsthafte Erkrankungen der Atemwege auslösen. Die Ursachen hierfür liegen (neben Planungsmängeln bei älteren Anlagen) hauptsächlich in ungenügender oder fehlerhafter Wartung. Beeinträchtigung durch RLT Ermittelt man die Ursachen für Gesundheitsbeschwerden in Innenräumen mit RLT-Anlagen zeigen objektive Studien, dass ein großer Anteil tatsächlich durch die Klima- und Lüftungsanlagen verursacht wird.
Beschwerden Gesundheitsbeschwerden durch mangelhafte RLT- und sind:
|
|
|
Biozide (Holzschutzmittel, Insektizide, Fungizide, Herbizide) Biozide sind in der Schädlingsbekämpfung eingesetzte Chemikalien oder Biochemikalien. Sie sind dazu bestimmt, auf chemischem oder biologischem Wege "Schadorganismen" (also Organismen, die der Mensch an dieser Stelle und/oder an diesem Ort nicht dulden möchte) zu zerstören, abzuschrecken und unschädlich zu machen. Die Eigenschaft, lebende Organismen abzutöten oder zumindest in ihrer Lebensfunktion einzuschränken, birgt auch das Risiko unerwünschter Wirkungen und Gefahren für die menschliche Gesundheit. Die in der Vergangenheit vielfach verwendeten Holzschutzmittel sowie Schädlingsbekämpfungsmittel sind ein häufiger Grund für Innenraumbelastungen in Wohnungen. Holzschutzmittelwirkstoffe  In den letzten Jahrzehnten wurden eine Vielzahl von Holzschutzmittelwirkstoffen verwendet. Das bekannteste Holzschutzmittel Pentachlorphenol (PCP) ist seit 1989 in Deutschland verboten. Bis in die frühen 80er-Jahre wurden jedoch häufig mit Holz ausgebaute Innenräume mit PCP-haltigen Holzschutzmitteln behandelt. Dies kann auch heute noch zu einer nachweisbaren Innenraumbelastung führen. Nachweismöglichkeiten sind - in der Raumluft (aktive Probennahme ) - im Holz, z.B. als Nachweis oder Beurteilung der Sanierungsbedürftigkeit - im Hausstaub - in Textilien oder Teppichböden Die Probennahme wird durch unsere Mitarbeiter in Anlehnung an die Richtlinien der Berufsgenossenschaften (BIA-Richtlinien) und die einschlägige Normen (VDI-Richtlinien) durchgeführt. Schädlingsbekämpfungsmittel Chlorinsektizide, Phosphorsäureester (z.B. Dichlorfos, Chlorpyrifos) und Pyrethroide (z.B. Permethrin) finden in Innenräumen als Schädlingsbekämpfungsmittel vielfältige Verwendung. Viele besitzen toxische bzw. neurotoxische Eigenschaften. In der Regel werden sie von Kammerjägern und auch Laien eingesetzt. Nach einer Schädlingsbekämpfungsmaßnahme können über einen langen Zeitraum erhöhte Biozidrückstände im Staub und der Innenraumluft auftreten.  DomoLytik Institut für Gebäude- und Innenraumanalytik GmbH
Kontakt aufnehmen |
|
|
Formaldehyd Formaldehyd ist ein Gas, das Augen und Schleimhäute reizt. Es steht im begründeten Verdacht, krebserregend zu sein (MAK-Liste). Quellen von Formaldehyd in Innenräumen sind: - Leime, Kleber auf Formaldehydbasis in Holzspanplatten - Möbel, Türen, Böden, Wand- und Deckenverkleidung aus Holzspanplatten - Teppiche - Tabakrauch Seit vielen Jahrzehnten werden Holzspanplatten im Möbelbau und im Innenausbau als Ersatz für die deutlich teureren Massivholzbretter eingesetzt. Grundmaterial sind Holzspäne, die aus Holzresten, Durchforstungsholz und Altholz gemahlen werden. Durch Zugabe von Bindemitteln (Klebern) können die Späne zu formstabilen Platten gepresst (Pressspanplatten) werden. Für diese Bindemittel werden in über 90% der Platten Kunstharze verwendet, die über die Produktlebensdauer der Platten Formaldehyd abgeben. Erst nach Zerfall der Platten (nach 30-50 Jahren) ist die Gefahr vorüber. Pressspanplatten werden in mehrere Emissionsklassen eingeteilt, die Auskunft über die Ausgleichskonzentration und damit über die Formaldehydabgabe an die Raumluft geben: F0= formaldehydfrei (z.B. zementgebundene Platten) E1= Ausgleichskonzentration Formaldehyd unter 0,1 ppm (part per million) E2= Ausgleichskonzentration Formaldehyd zwischen 0,1 und 1,0 ppm E1= Ausgleichskonzentration Formaldehyd über 1,0 ppm Das RAL-Umweltzeichen erhalten nur Platten mit einer Ausgleichskonzentration von unter 0.05 ppm. In Kombination mit geringen Luftwechselraten bei luftdichten Gebäudehüllen können sich aber auch hier wieder Innenraumkonzentrationen einstellen, die zu Gesundheitsrisiken führen. Für Formaldehyd sind Grenzwerte für die Innenraumbelastung festgelegt worden. Die Weltgesundheitsorganisation WHO sieht unterhalb einer Belastung von 0,042 ppm keinen oder wenig Grund zur Besorgnis. Als besorgniserregend stuft sie Belastungen ein, die 0,083 ppm überschreiten. Ähnlich das Bremer Umweltinstitut: Wenn eine "deutliche Belastung" von 0,05 bis 0,08 ppm vorliegt, sollten die Quellen ermittelt und mittelfristig entfernt werden. Eine hohe Konzentration von mehr als 0,08 ppm mache eine Sanierung erforderlich. Die stärkste Formaldehydquelle in Innenräumen ist übrigens Zigarettenrauch!  DomoLytik Institut für Gebäude- und Innenraumanalytik GmbH
Kontakt aufnehmen |
|
|
Flüchtige organische Verbindungen (VOC) VOC (Volatile Organic Compounds, also flüchtige organische Verbindungen) werden aus vielen Materialien der Bau-, Renovierungs- und Gebäudeausstattung abgegeben. Hierzu zählen beispielsweise die leicht flüchtigen Lösungsmittel in Lacken, Farben und Klebern, die mit dem Austrocknen bzw. Aushärten in die Raumluft abgegeben werden. In Neubauten bzw. frisch renovierten Gebäuden finden sich immer erhöhte Konzentrationen, die durch häufiges Lüften auf niedrigere Konzentrationen reduziert werden können. Schwerer flüchtige organische Substanzen aus (Dispersions-)Farben und Weichmachern aus Kunststoffen sind für das sogenannte "Fogging" in Wohnungen verantwortlich. Anzeichen kann z.B. eine auffällige Graufärbung an den Stellen mit niedriger Oberflächentemperatur sein.  DomoLytik Institut für Gebäude- und Innenraumanalytik GmbH
Kontakt aufnehmen |
|
|
Biozide (Holzschutzmittel, Insektizide, Fungizide, Herbizide) Biozide sind in der Schädlingsbekämpfung eingesetzte Chemikalien oder Biochemikalien. Sie sind dazu bestimmt, auf chemischem oder biologischem Wege "Schadorganismen" (also Organismen, die der Mensch an dieser Stelle und/oder an diesem Ort nicht dulden möchte) zu zerstören, abzuschrecken und unschädlich zu machen. Die Eigenschaft, lebende Organismen abzutöten oder zumindest in ihrer Lebensfunktion einzuschränken, birgt auch das Risiko unerwünschter Wirkungen und Gefahren für die menschliche Gesundheit. Die in der Vergangenheit vielfach verwendeten Holzschutzmittel sowie Schädlingsbekämpfungsmittel sind ein häufiger Grund für Innenraumbelastungen in Wohnungen. Holzschutzmittelwirkstoffe  In den letzten Jahrzehnten wurden eine Vielzahl von Holzschutzmittelwirkstoffen verwendet. Das bekannteste Holzschutzmittel Pentachlorphenol (PCP) ist seit 1989 in Deutschland verboten. Bis in die frühen 80er-Jahre wurden jedoch häufig mit Holz ausgebaute Innenräume mit PCP-haltigen Holzschutzmitteln behandelt. Dies kann auch heute noch zu einer nachweisbaren Innenraumbelastung führen. Nachweismöglichkeiten sind - in der Raumluft (aktive Probennahme ) - im Holz, z.B. als Nachweis oder Beurteilung der Sanierungsbedürftigkeit - im Hausstaub - in Textilien oder Teppichböden Die Probennahme wird durch unsere Mitarbeiter in Anlehnung an die Richtlinien der Berufsgenossenschaften (BIA-Richtlinien) und die einschlägige Normen (VDI-Richtlinien) durchgeführt. Schädlingsbekämpfungsmittel Chlorinsektizide, Phosphorsäureester (z.B. Dichlorfos, Chlorpyrifos) und Pyrethroide (z.B. Permethrin) finden in Innenräumen als Schädlingsbekämpfungsmittel vielfältige Verwendung. Viele besitzen toxische bzw. neurotoxische Eigenschaften. In der Regel werden sie von Kammerjägern und auch Laien eingesetzt. Nach einer Schädlingsbekämpfungsmaßnahme können über einen langen Zeitraum erhöhte Biozidrückstände im Staub und der Innenraumluft auftreten.  DomoLytik Institut für Gebäude- und Innenraumanalytik GmbH
Kontakt aufnehmen |
|
|
Formaldehyd Formaldehyd ist ein Gas, das Augen und Schleimhäute reizt. Es steht im begründeten Verdacht, krebserregend zu sein (MAK-Liste, Maximale-Arbeitsplatz-Konzentration). Quellen von Formaldehyd in Innenräumen sind: - Leime, Kleber auf Formaldehydbasis in Holzspanplatten - Möbel, Türen, Böden, Wand- und Deckenverkleidung aus Holzspanplatten - Teppiche - Tabakrauch Seit vielen Jahrzehnten werden Holzspanplatten im Möbelbau und im Innenausbau als Ersatz für die deutlich teureren Massivholzbretter eingesetzt. Grundmaterial sind Holzspäne, die aus Holzresten, Durchforstungsholz und Altholz gemahlen werden. Durch Zugabe von Bindemitteln (Klebern) können die Späne zu formstabilen Platten gepresst (Pressspanplatten) werden. Für diese Bindemittel werden in über 90% der Platten Kunstharze verwendet, die über die Produktlebensdauer der Platten Formaldehyd abgeben. Erst nach Zerfall der Platten (nach 30-50 Jahren) ist die Gefahr vorüber. Pressspanplatten werden in mehrere Emissionsklassen eingeteilt, die Auskunft über die Ausgleichskonzentration und damit über die Formaldehydabgabe an die Raumluft geben: F0= formaldehydfrei (z.B. zementgebundene Platten) E1= Ausgleichskonzentration Formaldehyd unter 0,1 ppm (part per million) E2= Ausgleichskonzentration Formaldehyd zwischen 0,1 und 1,0 ppm E1= Ausgleichskonzentration Formaldehyd über 1,0 ppm Das RAL-Umweltzeichen erhalten nur Platten mit einer Ausgleichskonzentration von unter 0,05 ppm. In Kombination mit geringen Luftwechselraten bei luftdichten Gebäudehüllen können sich aber auch hier wieder Innenraumkonzentrationen einstellen, die zu Gesundheitsrisiken führen. Für Formaldehyd sind Grenzwerte für die Innenraumbelastung festgelegt worden. Die Weltgesundheitsorganisation WHO sieht unterhalb einer Belastung von 0,042 ppm keinen oder wenig Grund zur Besorgnis. Als Besorgnis erregend stuft sie Belastungen ein, die 0,083 ppm überschreiten. Ähnlich das Bremer Umweltinstitut: Wenn eine "deutliche Belastung" von 0,05 bis 0,08 ppm vorliegt, sollten die Quellen ermittelt und mittelfristig entfernt werden. Eine hohe Konzentration von mehr als 0,08 ppm mache eine Sanierung erforderlich. Die stärkste Formaldehydquelle in Innenräumen ist übrigens Zigarettenrauch!  DomoLytik Institut für Gebäude- und Innenraumanalytik GmbH
Kontakt aufnehmen |
|
|
Flüchtige organische Verbindungen (VOC) VOC (Volatile Organic Compounds, also flüchtige organische Verbindungen) werden aus vielen Materialien der Bau-, Renovierungs- und Gebäudeausstattung abgegeben. Hierzu zählen beispielsweise die leicht flüchtigen Lösungsmittel in Lacken, Farben und Klebern, die mit dem Austrocknen bzw. Aushärten in die Raumluft übergehen. In Neubauten bzw. frisch renovierten Gebäuden finden sich immer erhöhte Konzentrationen, die durch häufiges Lüften auf niedrigere Konzentrationen reduziert werden können. Schwerer flüchtige organische Substanzen aus (Dispersions-)Farben und Weichmachern aus Kunststoffen sind für das sogenannte "Fogging" in Wohnungen verantwortlich. Anzeichen kann z.B. eine auffällige Graufärbung an den Stellen mit niedriger Oberflächentemperatur sein.  DomoLytik Institut für Gebäude- und Innenraumanalytik GmbH
Kontakt aufnehmen |
|
|
Flüchtige organische Verbindungen mikrobiellen Ursprungs (MVOC) MVOC (Microbial Volatile Organic Compounds) sind bevorzugt bei Feuchtigkeitsschäden des Gebäudes in der Raumluft anzutreffen. Bei ihnen handelt es sich um Stoffwechselprodukte von Bakterien und Schimmelpilzen, die zum Teil für einzelne Schimmelarten charakteristisch sind und z.B. den muffig-moderigen Geruch ausmachen. MVOC können sich in der Raumluft auch bei versteckten Schimmelpilzschäden finden. Sie liefern einen Hinweis, jedoch ist ihr Auftreten nicht zwingend mit Schimmelpilzschäden assoziiert. Ein Schimmelpilzspürhund kann mit Hilfe von ausgasenden MVOC die Schimmelpilzquelle identifizieren.  DomoLytik Institut für Gebäude- und Innenraumanalytik GmbH
Kontakt aufnehmen |
|
|
Künstliche Mineralfasern (KMF) Zu den KMF zählt man u.a. Glas- und Steinfasern. Hergestellt werden sie aus Glas- oder Steinschmelzen, die durch sehr feine Düsen gepresst werden. Zusammen mit Bindemitteln werden KMF zu Platten verarbeitet, die auf Grund ihres hohen Luftanteils ein gutes Wärmedämmverhalten aufweisen und bei der Wärme- und Schalldämmung von Gebäuden eine breite Verwendung finden. In den 70er-Jahren wurde nachgewiesen, dass Asbest (eine natürliche Mineralfaser!) auf Grund ihrer Fasergeometrie nachweislich Lungenkrebs verursacht. Wegen ihrer ähnlichen geometrischen mikroskopischen Struktur gerieten auch die KMF in Verdacht. In der Folge kam eine zweite Generation KMF auf den Markt, deren Fasern eine größere Biolöslichkeit aufweisen. Dazu muss der Kanzerogenitätsindex Ki >= 40 liegen. Dies wird erreicht, wenn der Filamentdurchmesser größer als 3 µm ist, also die Fasern nicht lungengängig sind oder der Nachweis einer ausreichend hohen Biolöslichkeit im Tierversuch erbracht werden kann. Dabei bezieht sich die Biolöslichkeit auf die Halbwertzeit der KMF im Lungengewebe, die unter 40 Tagen liegen muss. Hierbei bedeutet eine hohe Biolöslichkeit eine niedrige Halbwertzeit. Biopersistente Fasern, also Fasern mit geringer Biolöslichkeit, darunter fallen Glas- oder Steinwollen, die vor ca. 1995 hergestellt wurden, dürfen nicht mehr verkauft werden. Sie sind jedoch in vielen Altbauten noch verbaut. Vor Sanierungs- oder Abbrucharbeiten sind deshalb entsprechende Materialanalysen durchzuführen. Bei positivem Befund - Ki-Index < 40 - sind die entsprechenden Arbeitsschutzmaßnahmen zu berücksichtigen. Bei vorhandener und intakter innenseitiger Dampfsperrfolie ist es jedoch nicht notwendig, die älteren Dämmstoffe zu entfernen. Dabei würden viele Fasern freigesetzt und die Raumluft entsprechend hoch belastet werden. Räume, in denen Mineralfaserdämmstoffe nicht mit Aluminium- oder Kunststofffolie abgedeckt sind, also Fasern der Raumluft frei zugänglich vorliegen, sollten dringend saniert werden.
Vorteile von KMF sind ihre Beständigkeit gegen Schimmel, Pilze und Insekten.  DomoLytik Institut für Gebäude- und Innenraumanalytik GmbH
Kontakt aufnehmen |
|
|
Asbest Asbest wurde bis in die 70er-Jahre auch "Wunderfaser" genannt, weil es eine große Festigkeit besitzt und hitzebeständig ist. Diese Hitzebeständigkeit führte dazu, dass Spritzasbest zum vorbeugenden Brandschutz vor allem bei Stahlskelettbauten eingesetzt wurde. Aufgrund der Kanzerogenität (z.B. Auslösen von Lungen- und Rippenfelltumoren) der lungengängigen Asbestfasern, ist der Einsatz von Asbest heute in vielen Ländern verboten, unter anderem in der ganzen EU. Asbest stellt heute primär ein Entsorgungsproblem dar, kann aber nach Rückfrage mit den zuständigen Stellen bei Privatpersonen meist staubdicht verpackt auf normalen Hausmülldeponien entsorgt werden. Bei der Beurteilung ist die Erkennung von Spritzasbest fast immer ein Anzeichen für baldige Sanierungsmaßnahmen. Unproblematischer ist zementgebundenes Asbest, das in Plattenform bis Ende der 80er-Jahre u.a. zur Dach- und Fassadenverkleidung eingebaut wurde. Sind die Platten nicht verwittert und sind keine offenen Fasern zu erkennen, muss nicht notwendigerweise sofort saniert werden.   DomoLytik Institut für Gebäude- und Innenraumanalytik GmbH
Kontakt aufnehmen |
|
|
Polychlorierte Biphenyle (PCB) Polychlorierte Biphenyle sind toxische und krebserregende Chemikalien, die bis in die 80er-Jahre vor allem als Weichmacher in Dichtmassen und Kunststoffen, in Transformatoren, elektrischen Kondensatoren und als Hydraulikflüssigkeit verwendet wurden. PCB zählen auf Grund ihrer geringen biologischen Abbaubarkeit und ihrer langen Persistenz in der Umwelt zu den zwölf als "dreckiges Dutzend" bekannten organischen Giftstoffen, welche weltweit verboten wurden.  In der Zeit von 1960 bis 1989 wurden PCB als Weichmacher dem Dichtungsmaterial zwischen Betonbauteilen (Dehnungsfugen) zugesetzt. PCB gasen über längere Zeiträume aus und belasten die Raumluft in Gebäuden. Vor allem im öffentlichen Gebäudebestand fand in den letzten Jahren ein Austausch der Dichtmassen statt, wenn PCB nachgewiesen wurden. PCB können sowohl in Materialproben als auch in der Raumluft analytisch nachgewiesen werden.  DomoLytik Institut für Gebäude- und Innenraumanalytik GmbH
Kontakt aufnehmen |
|
|
Feinstaub In den letzten Jahren wurden massive Anstrengungen unternommen, den Feinstaubgehalt der Außenluft abzusenken. Die Diskussion um Fahrverbote ist noch nicht abgeschlossen. Doch liegt in Wohn-, aber auch in öffentlichen Gebäuden die Belastung mit Feinstaub oft doppelt so hoch wie im Freien. Da der Mensch über 80% seiner Zeit in geschlossenen Räumen verbringt, hat die schlechte Luft im Inneren eine weitaus größere gesundheitliche Bedeutung. Untersuchungen in Haushalten zeigten, dass in jeder dritten Wohnung die Konzentration über 50 Mikrogramm Feinstaub je Kubikmeter Luft liegt. Dieser Grenzwert darf im Freien lediglich an 35 Tagen im Jahr überschritten werden. Es gibt sogar Wohnungen, in denen an jedem Tag im Jahr mehr Staub in der Luft schwebt, als in der Außenluft zulässig. Der Innenraum kommt deshalb bei der gegenwärtigen Feinstaubdiskussion viel zu kurz. In Schulen findet sich ein ähnliches Bild. Untersuchungen des Landesamtes für Arbeitsschutz in Berlin im Juni 2006 belegen, dass der Feinstaub in vierzig Berliner Schulen in fast allen Klassenzimmern über dem Grenzwert von 50 Mikrogramm je Kubikmeter Luft lag. Im Mittel war die Konzentration sogar doppelt so hoch wie in der Außenluft der unmittelbaren Umgebung der Schulen. Besonders "dicke Luft" herrscht in Raucherwohnungen und in Büros. Hier wurden Messwerte bis zum 20-Fachen der Grenzwerte für Außenluft entdeckt. Der Feinstaub setzt sich aus für die Augen unsichtbaren Teilchen zusammen, die maximal einige tausendstel Millimeter (Mikrometer) groß sind, teilweise aber auch nur Dimensionen von einigen milliardstel Millimetern (Nanometer) aufweisen. Vor allem die sehr kleinen Vertreter dringen tief in die Lunge vor. Sie gelangen über die Lungenbläschen ins Blut und in weitere Organe. Der Feinstaub reizt und schädigt auf diese Weise sowohl die Lunge als auch entfernt liegendes Körpergewebe. Der Feinstaub erhöht eindeutig das Risiko für Infarkte und Herz-Kreislauf-Erkrankungen. Extrembeispiel ist hier sicherlich die sogenannte Staublunge bei Bergarbeitern, die zeitlebens einer hohen Feinstaubbelastung ausgesetzt waren. Besonders deutlich reagieren Allergiker und Asthmatiker nach dem Einatmen der Partikel. Wahrscheinlich verhält sich der Feinstaub so aggressiv, weil sich viele Fremdstoffe an die kleinen Partikel heften können. So klammern sich in Wohnungen Allergene von der Hauskatze ebenso wie Chemikalien aus Teppichen (z.B. Pyrethroide), Computern (Flammschutzmittel) oder Möbeln an die Teilchen. Selbst eigentlich nicht luftgängige Substanzen können so den Weg in die Raumluft finden. Bei Kerzen und Kaminfeuern lagern sich krebserregende Verbrennungsrückstände an die Partikel an. Je nach Lage der Wohnung speist sich der Staub im Inneren etwa zur Hälfte aus dem Feinstaub von draußen. Daneben verschlechtern Zigaretten, Kerzen und offene Kamine die Luft in den eigenen vier Wänden. Auch beim Kochen und Braten werden Partikel in die Luft geschleudert, die sich jedoch mit Dunstabzugshauben absaugen lassen. Besondere Bedeutung für die Feinstaubbelastung in Bürogebäuden haben Kopierer und Drucker, vor allem Laserdrucker.  DomoLytik Institut für Gebäude- und Innenraumanalytik GmbH
Kontakt aufnehmen |
|
|
Elektromagnetische Strahlung in Gebäuden Die Installation und Verwendung bestimmter Technologien wie z.B. Radio, Fernsehen, Mobilfunk, WLAN, GPS-Navigation, aber auch Mikrowellengeräte führen in der Umgebung des Menschen zu elektromagnetischen Feldern. Im Gegensatz zu ionisierender Strahlung reicht die Energie dieser Strahlung nicht aus, um Atome und Moleküle elektrisch aufzuladen. Auf allen Ebenen (Medien, Wissenschaft und Politik) wird zur Zeit diskutiert, ob diese Strahlung im normalen Umgang gesundheitliche Folgen haben kann. Unterschiedliche Konzepte dienen hier zur Vorsorge. Wir messen die in Ihrer Umgebung vorhandenen elektrischen und magnetischen Felder und zeigen Ihnen, ob die nationalen und europäischen Grenzwerte eingehalten werden. Falls gewünscht, zeigen wir Ihnen auf biophysikalischer Basis, welche und wie geeignete Abschirmmaßnahmen diese Felder reduzieren können.  DomoLytik Institut für Gebäude- und Innenraumanalytik GmbH
Kontakt aufnehmen |
|
|
Ionisierende Strahlung Allgemein Zur ionisierenden Strahlung zählt die ultraviolette Strahlung, Röntgen- und Gammastrahlung sowie Partikelstrahlung wie z.B. Alpha-, Beta- und Neutronenstrahlung. Ionisierende Strahlung ist wissenschaftlich nachgewiesen krebserregend und erbgutschädigend. Neben akuten kann es auch zu bleibenden Strahlenschäden kommen - sowohl bei den betroffenen Personen als auch den Nachkommen. Die Dosis ionisierender Strahlung sollte so gering wie möglich sein, ob es überhaupt einen unschädlich niedrigen Grenzwert gibt, ist wissenschaftlich umstritten. Eine Ausnahme bildet hier die ultraviolette Strahlung, die in geringer Dosis sogar lebensnotwendig ist und gegen die viele Organismen bei gemäßigter Belastung geeignete Abwehrstrategien entwickelt haben (z.B. Hautbräunung bei hellhäutigen Menschen). Ein großer Anteil der natürlichen ionisierenden Strahlung entsteht durch den radioaktiven Zerfall von Radon, der in Abhängigkeit der geographischen Lage große Schwankungsbreiten aufweist. Strahlung aus Baumaterialien In 90% aller Innenräume ist eine höhere Strahlenbelastung zu verzeichnen als im Freien. Neben der schon beschriebenen Belastung durch Radon spielen hier auch die verwendeten Baumaterialien (z.B. radioaktives Thorium in einzelnen Graniten oder uranhaltige Fliesenglasuren) eine große Rolle. Idealerweise sollten sich aber die Strahlenwerte außerhalb- und innerhalb eines Gebäudes nicht unterscheiden. Wir messen und bewerten die in Ihrer Umgebung vorhandene ionisierende Strahlung und machen Ihnen, falls dies notwendig sein sollte, Vorschläge zu deren Reduzierung.  DomoLytik Institut für Gebäude- und Innenraumanalytik GmbH
Kontakt aufnehmen |
|
|
Gesünder Wohnen - Gesünder arbeiten,
dies ist die Philosophie des Instituts für Gebäude- und Innenraumanalytik. Unser Ziel ist daher, ein gesundes Lebensumfeld für eine hohe Lebensqualität zu schaffen. Dazu sind unbelastete Wohn- und Arbeitsräume notwendig. Besondere Bedeutung hat hier die Luftqualität. Durchschnittlich 45.000 l Luft atmet eine erwachsene Person ohne körperliche Belastung täglich. Auf diese Weise führen selbst geringe Raumluftbelastungen durch Akkumulationseffekte häufig zu sowohl akuten als auch chronischen gesundheitlichen Beschwerden und Erkrankungen. Bei allen Nahrungsmitteln ist heutzutage schon gesetzlich vorgeschrieben, dass sie frei von biologischen Krankheitserregern sind und Grenzwerte für chemische Schadstoffe einhalten. Bei "Bio-"Lebensmitteln werden noch niedrigere chemische Belastungen für den Konsumenten erwartet. Doch was wissen wir über die Luft, die wir einatmen? Das Institut für Gebäude- und Innenraumluftanalytik bietet die gleiche Sicherheit für die Atemluft an. Von uns analysierte Häuser erhalten - auf Wunsch - das Siegel "Gesunde Immobilie", wenn sie frei von Schadstoffen sind bzw. gewisse Grenzwerte nicht überschreiten. Darauf können Sie sich verlassen! Ein Großteil der chemischen Schadstoffe, der biologischen und der physikalischen Beeinträchtigungen ist für den Menschen mit seinen Sinnesorganen jedoch nicht wahrnehmbar. Wir überprüfen deshalb mit analytischen Messinstrumenten, ob und - wenn ja - in welcher Höhe eine Innenraumbelastung in Ihrem Wohn- bzw. Bürogebäude vorliegt. Je nach Umfang der Untersuchung und Einhaltung der unten stehenden Qualitätskriterien erhalten Sie dazu das Immobiliensiegel, besonders für Bewohner, Verkäufer und Käufer von Immobilien stellt dies einen nicht bezifferbaren Wert dar. Gebäudecheck für Wohngesundheit Bei dem Gebäudecheck werden Schimmelpilze, Holz zerstörende Pilze und Insekten, für das Baualter und den Baustandard typische chemische Substanzen sowie radioaktive Belastungsquellen und Elektrosmog berücksichtigt. Das Pauschalhonorar für diese Ersteinschätzung beläuft sich auf 495,- Euro (inkl. MwSt.). Dafür erhalten Sie das Qualitätssiegel "Gesunde Immobilie" Kategorie A mit einem Prüfbericht, in dem möglicherweise aufgefundene Schwachpunkte und Gesundheitsgefahren für die Bewohner sowie Sanierungsempfehlungen erläutert sind. Damit Ihr Traumhaus nicht zum Albtraum wird! Biologische, chemische und physikalische Beeinträchtigungen sind mess- und analysierbar. Der Gebäudesachverständige legt bei der Inspektion des Gebäudes nach Absprache mit dem Eigentümer/Nutzer fest, ob und welche weitergehenden Analysen sinnvoll sind (Kategorie AA-AAAA). Voraussetzung für die Erteilung des Siegels der Kategorien AA - AAAA und zugleich Garantie für seine Qualität ist die Einhaltung der jeweils strengsten gesetzlichen Grenzwerte für chemische Schadstoffe (national, EU und WHO) und der Empfehlungen der Gesundheits- und Landesumweltämter für biologische Schadstoffe. Ergänzend kann auch eine detaillierte Begutachtung der Immobilie durch einen Innenraumanalytiker beauftragt werden, bei der auch nach versteckten Belastungsquellen gesucht und eventuell notwendige Bauteilöffnungen vorgenommen werden. Dabei findet eine umfangreiche Ursachenanalyse statt, es werden notwendige biologische, chemische und/oder physikalische Messungen durchgeführt sowie detaillierte Sanierungsmaßnahmen mit einer Kosteneinschätzung vorgeschlagen. Diese Leistungen werden von einem Sachverständigen für Innenraumuntersuchungen erbracht und transparent nach dem maßgeblichen amtlichen JVEG (Justiz Vergütungs- und Entschädigungsgesetz) abgerechnet." Das Honorar liegt erfahrungsgemäß zwischen 800,- bis 2500,- Euro und ist sowohl von der Objektgröße als auch vom Umfang und der Vielfalt der Schadstoffbelastung abhängig.  DomoLytik Institut für Gebäude- und Innenraumanalytik GmbH
Kontakt aufnehmen
Vorteile des Qualitätssiegels "Gesunde Immobilie" für Bewohner und bei Immobilienverkäufen
Mit dem Siegel für gesünderes Wohnen schaffen wir erstmalig die Möglichkeit, das Raumklima eines Gebäudes objektiv zu beurteilen. Das Siegel zeigt Ihnen, dass dieses Gebäude einer sehr strengen, umfangreichen Kontrolle durch einen Sachverständigen und zusätzlich einer Analyse auf chemische Schadstoffe, biologische Belastungen und/oder physikalische Beeinträchtigungen unterzogen wurde. Die angewandten Qualitätskriterien sind jeweils die strengsten nationalen, europäischen und WHO-Richtlinien. Mit der Erteilung des Siegels erhalten Sie eine Urkunde, die den durchgeführten Untersuchungsumfang dokumentiert und bescheinigt, dass alle Richtlinien - bezogen auf die durchgeführten Analysen - eingehalten werden bzw. zeigen Ihnen Optimierungsmöglichkeiten auf. In dem beigefügten Bericht nehmen wir detaillierter zu den einzelnen Punkten Stellung. Steigern Sie Ihre Gesundheit und Lebensqualität Zeigen Sie Ihr Gesundheitsbewusstsein und vergewissern Sie sich, dass die Innenraumluft frei von Schadstoffen ist, bzw. lassen Sie sich aufzeigen, wie Sie die Innenraumluft verbessern können. Sichern Sie damit die Gesundheit und Lebensqualität Ihrer Familie. Signalisieren Sie beim Verkauf Ihrer Immobilie ein starkes Qualitätsbewusstsein Als Immobilienverkäufer zeigen Sie, dass Sie verantwortungsbewusst mit Ihrer Immobilie umgegangen sind. Unsere Statistik zeigt, dass sich beim Verkauf eines mit unserem Siegel ausgezeichneten Hauses ein durchschnittlicher Mehrerlös von 5,3% erzielen lässt. Unsere Vorgehensweise 1. Kontaktaufnahme und gemeinsame telefonische Vorbesprechung mit Übermittlung wichtiger Kenndaten zum zu untersuchenden Gebäude, Zusendung eines für die Gebäudeklasse spezifischen Fragenkatalogs. 2. Begehung des Gebäudes durch einen Gebäudesachverständigen zur Erkennung möglicher Belastungen, Dokumentation der Ergebnisse 3. je nach Vereinbarung und falls notwendig: Probennahme (Luft- und/oder Materialproben) und Laboranalyse 4. bei Einhaltung der Grenz- und Richtwerte: Erteilung des Siegels. Der beigefügte Bericht zeigt außerdem potenzielle Problembereiche auf, beantwortet die Fragen zur Ursache, Sanierungsdringlichkeit und langfristigen Abhilfemaßnahmen. 5. telefonische Beratung bei Unklarheiten und offenen Fragen  DomoLytik Institut für Gebäude- und Innenraumanalytik GmbH
Kontakt aufnehmen
Ablauf der Gebäudeuntersuchung
Das Qualitätssiegel "Gesunde Immobilie" Kategorie A bieten wir zu einem günstigen Pauschalhonorar von 495,- Euro an. Diese Konditionen sind nur möglich, weil Sie uns mithelfen, den Verfahrenablauf möglichst schnell und nach Gebäude- und Altersklasse standardisiert zu organisieren. Dadurch wird auch die gleichbleibend hohe Qualität der Ergebnisse gewährleistet. Aus Umwelt-, Geschwindigkeits-, und Kostengründen arbeiten wir bevorzugt per E-Mail, Internet und Telefon. Der Postweg ist auch möglich, er führt jedoch bei jedem Briefwechsel zu 3 bis 4 Tagen Zeitverlust. Für die ideale Abwicklung des Untersuchungsauftrages hat sich das folgende Vorgehen bewährt: 1. Sie nehmen über unsere Kontaktseite oder telefonisch mit uns Verbindung auf. In diesem Schritt sind wir an der Adresse und einigen technischen Daten des Gebäudes interessiert. Teilen Sie uns bitte auch Besonderheiten mit. 2. Wir übersenden Ihnen einen für die Gebäudeklasse und das Gebäudealter spezifischen Fragebogen per E-Mail (auch per Post möglich). 3. Sie senden uns den am Computer ausfüllbaren Fragebogen per E-Mail zurück (alternativ den handschriftlich ausgefüllten Fragebogen per Post). 4. Ein Mitarbeiter von DomoLytik (bei Untersuchungsaufträgen in NRW und dem Rhein-Main- Gebiet) oder ein von uns nach fachlicher Kompetenz ausgewählter Kooperationspartner (im übrigen Bundesgebiet) wird sich mit Ihnen innerhalb von 3 Werktagen (nach Eingang des Fragebogens bei DomoLytik) in Verbindung setzen. Sie vereinbaren einen Begehungstermin mit dem Gebäudesachverständigen und planen bitte zwei bis drei Stunden Zeit dafür ein. 5. Am vereinbarten Termin begeht der Gebäudesachverständige mit Ihnen zusammen das Gebäude. Bitte stehen Sie dabei den gesamten Zeitraum für Rückfragen zur Verfügung. Im Rahmen des Immobiliensiegels "Gesunde Immobilie" werden bei dieser Ersteinschätzung die für den Sachverständigen offensichtlichen und offen zugänglichen potenziellen Belastungsquellen für die Gesundheit der Bewohner erfasst. Es werden jedoch keine Bauteilöffnungen vorgenommen, um z.B. versteckte Belastungsquellen aufzuspüren. Weiterhin werden einfache messtechnische Analysen vorgenommen, z.B. um bei vorgefundenen Feuchtigkeits-/Schimmelpilzschäden die Ursache aufzuzeigen, jedoch keine Laborleistungen z.B. auf chemische Schadstoffe beauftragt. Wünschen Sie zu einzelnen Fragestellungen weiter-/tiefergehende Untersuchungen bzw. Analysen, teilen Sie dies bitte dem Sachverständigen bei der Begehung mit, damit eine mögliche Probennahme noch im Objekt stattfinden kann. 6. Nach der Begehung erhalten Sie auf Wunsch eine kurze mündliche, unverbindliche Vorabinformation. Den Kurzbericht mit Sanierungshinweisen (falls notwendig) erhalten Sie innerhalb von 3 Werktagen per E-Mail (auf Wunsch per Post). Beiliegend erhalten Sie ein Anschreiben sowie eine auf das zu untersuchende Gebäude bezogene Rechnung. 7. Danach und natürlich auch während der Punkte 1. bis 6. stehen wir Ihnen gerne für Fragen telefonisch und per E-Mail zur Verfügung.  DomoLytik Institut für Gebäude- und Innenraumanalytik GmbH
Kontakt aufnehmen 
Gestaffelt nach Umfang der Untersuchungen werden folgende Qualitätsurkunden mit entsprechenden Siegeln erteilt: A => Ein Sachverständiger für Innenraumanalytik hat die Immobilie inspiziert und keine, für den Fachmann offensichtliche Schadstoffe aufgefunden bzw. aufgefundene Schadstoffe in dem beiliegenden Bericht dokumentiert. AA => Ein Sachverständiger für Innenraumanalytik hat die Immobilie inspiziert und Analysen auf chemische Schadstoffe vorgenommen oder biologische Beeinträchtigungen oder physikalische Beeinträchtigungen analysiert (1 von 3) und keine, für den Fachmann offensichtliche und zu messenden Schadstoffe aufgefunden bzw. aufgefundene Schadstoffe in dem beiliegenden Bericht dokumentiert. AAA => Ein Sachverständiger für Innenraumanalytik hat die Immobilie inspiziert und Analysen auf chemische Schadstoffe vorgenommen und/oder biologische Beeinträchtigungen und/oder physikalische Beeinträchtigungen analysiert (2 von 3) und keine, für den Fachmann offensichtliche und zu messenden Schadstoffe aufgefunden bzw. aufgefundene Schadstoffe in dem beiliegenden Bericht dokumentiert. AAAA => Ein Sachverständiger für Innenraumanalytik hat die Immobilie inspiziert und Analysen auf chemische Schadstoffe vorgenommen und biologische Beeinträchtigungen und physikalische Beeinträchtigungen analysiert (alle 3) und keine, für den Fachmann offensichtliche und zu messenden Schadstoffe aufgefunden bzw. aufgefundene Schadstoffe in dem beiliegenden Bericht dokumentiert.  DomoLytik Institut für Gebäude- und Innenraumanalytik GmbH
Kontakt aufnehmen   DomoLytik Institut für Gebäude- und Innenraumanalytik GmbH
|
|
|
|
|
|
|
|
|
|
|
|
|
|
|
|
|
